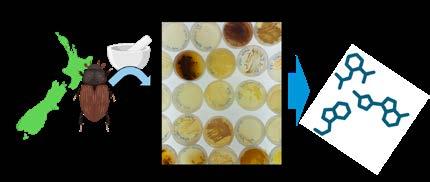

2024
TE PŪTEA RANGAHAU A MARSDEN
MARSDEN FUND UPDATE

30TH ANNIVERSARY EDITION
![]()
TE PŪTEA RANGAHAU A MARSDEN
MARSDEN FUND UPDATE

30TH ANNIVERSARY EDITION
1980 - 2025

I am a student, a learner, a Research assessor
Everyday a lesson in the University of Advancing Knowledge
(Institution code UAK)
I may need a new label
I’m a bio-geo-chemo-physicoastro-ethno-econo-socio-ologist
Words known
ophiolite, bathymetic, laser ablation inductively coupled mass spectroscopy
Words learnt ethnography, transcriptomics, optical frequency combs
Words never understood
if two curves are such that their pullback under multiplication by 2 in their respective Jacobians produce curves such that their Jacobians are isogenous...
I am a greeter, a kaimanaaki, a people-matcher
Names and codes become faces and connections over scones (gluten-free available)
Everyone brings their own kete to Kete
Nā te rourou, nā taku rourou
We network
Barabási-Albert could model us, is our hub of an unusually high degree?
We evolve a phylogeny of philosophy, an academy adapting
We expand beyond the sum of our parts
this University a universe, our galaxy of geeks, Apārangi in orbit
A POEM BY HEIDI DE RONDE FORMER KAIAROTAKE RANGAHAU RESEARCH ASSESSOR AT THE ROYAL SOCIETY TE APĀRANGI
(Apārangi = a group of experts; the planet Mercury)

PUTANGA ISSUE NO.60
30 YEAR REVIEW AND 2024 PROJECT HIGHLIGHTS
Supported by the New Zealand Government with funding from the Ministry of Business, Innovation and Employment. Nā Te Hīkina Whakatutuki te mana hāpai.
05/ MARSDEN FUND FAST-START AWARDS 91
It’s electric: Investigating new methods for diagnosing gastric disorders 92
Biocontrol blues: Did a virus sabotage the control of one of our most damaging pasture pests? 93
Why do our hearts fail at high temperatures?
Investigating the effect of heat stress on mitochondria from healthy and diseased hearts 94
Whiria te tangata: Understanding the importance of traditional clothing making 96
Whiria te tangata: Te mārama ki te hiranga o ngā tikanga hanga kākahu 97
Solving the mystery of the legendary Haowhenua earthquake 98
Te rapu i te māramatanga o te rū rongonui o Haowhenua 99
Predicting future flow: Building better models of glacier and ice sheet flow 100
Braving big emotions: Reducing the incidence of self-harm in our young people 102
Harnessing the power of insect symbionts to combat antimicrobial resistance 103
Ngā kōrero tawhito: A review of traditional language expression 104
Ngā kōrero tawhito: He arotake i te rere o te reo tuku iho 105
How do plants hear sound? 106
06/ MARSDEN FUND IN FOCUS AND MARSDEN FUND NEWS 109
Auckland Writers Festival 110
Dramatic decline in Tongariro’s native plants as invasive heather spreads 112 New protein discovery may influence future cancer treatment 114
Digital infant in world-first psychology research 116
Guam collaboration improving understanding of gout in the Pacific 118
07/ MARSDEN FUND RECIPIENTS 2024 120
In 1994, Rt Hon Simon Upton PC FRSNZ, then Minister of Research, Science and Technology, had a bold vision for fundamental research when he established the Marsden Fund. Its initial objectives were to underpin our scientific knowledge and deepen our research skill-base, with grants awarded on the basis of ingenuity and the likelihood of generating some ‘first-class science’. And what first-class research we have seen in 30 years!
From the outset, receiving a Marsden Fund grant was recognised as a hallmark of excellence –through which excellent researchers would pursue their boldest ideas. The first black hole has been photographed, planets discovered, ancient civilisations unearthed, energy sources explored, technology and medicine advanced, climate knowledge expanded, legal systems challenged, culture revitalised. We know more about our settlement in these lands. Put short, we have increased our knowledge about our world and ourselves, built innovation and capacity, supported careers, and augmented the place of Aotearoa New Zealand research on the world stage.
Of course, first-class research is borne from more than great ideas. Far more often than not, it takes years of collaboration, institutional support, and a mosaic of funding before downstream benefits are delivered. In reflecting on the Marsden Fund within the wider system, we are proud of the many ways it has been a pivotal agent of change.
In this 30-year review, we have selected a few of the many areas of research where Marsden Fund has had, and continues to exert, notable impacts. For example, the first grant received here to pursue Antarctic research was from the Marsden Fund. Its timing was critical, supporting early ice-core drilling expeditions and expediting the establishment of the Antarctic Research Centre. We hope you enjoy reading this and other Marsden Fund stories of innovation and scientific pursuit in this edition.
We are grateful to Simon Upton and those who initiated the Fund. We must also acknowledge those who manage the many applications that flood through the doors every February, and who ensure that the process is fair and identifies the most excellent work available. This includes the many thousands of overseas referees who have provided independent assessments over the years.
Finally, I acknowledge the investigators themselves who have worked to create the most exciting and innovative research projects that one could imagine, in many cases persevering over several years to fine-tune an idea to excellence.

At any significant anniversary we should not only reflect back on our past but also look to the future. In this regard, the Government has set clear priorities for investments generating economic, environmental, or health benefits for New Zealand. Funding for interdisciplinary research that generates new ideas is a smart, strategic investment that lays the foundation for a better, more prosperous future. We have
exceptional research talent in this country, across a broad range of disciplines, and our focus continues to be on the key objectives of excellence, connectivity, diversity, and scholarly impact.
Māuri ora!
Professor Gill Dobbie FRSNZ Marsden Fund Council Chair
I whakatūria te Pūtea Rangahau a Marsden i te 30 tau ki mua hei whakatairanga i te rangahau kairangi e taea ai ngā hua pūmau mō Aotearoa. Ka tohua he Kaunihera e te Minita Pūtaiao, Aronga Hou me te Hangarau kia tokoiwa ngā kairangahau mātanga hei ārahi i ngā haumitanga a te Kāwanatanga a te Pūtea Rangahau a Marsden.
He pūtea whakataetae te Pūtea Rangahau a Marsden, arā, ka whakataetae ngā kairangahau mātāmua o Aotearoa ki te tūhura i ā rātau tino whakaaro mā te whai i ngā tikanga rangahau pakari. Ka arotakehia e ngā pae whiriwhiri tokowaru ā rātau tono, me te uru mai o ngā arotake aropā motuhake o tāwāhi, kātahi ka tohua ngā kaupapa papai rawa o ia wāhanga. Ka arotakehia e te Kaunihera Pūtea Rangahau a Marsden, ko Ahorangi Gill Dobbie FRSNZ te heamana i tēnei wā, ngā tīpakonga katoa a ngā pae whiriwhiri mai i ngā peka mātauranga katoa, ā, ka whakatau ko ēhea ngā kaupapa ka whiwhi pūtea.
Atu ki te toru ngā momo takuhe ka āhei ngā kairangahau ki te tono.
• Te Kaunihera Pūtea Rangahau a Marsden, atu ki te $3 miriona te wāriu mō te 3 tau.
• Ngā takuhe arowhānui, atu ki te $960,000 te wāriu mō te 3 tau.
• Ngā takuhe Tīmata-Wawe, mō ngā kairangahau pūhou, he $360,000 te wāriu mō te 3 tau.
He whakahaere huamoni-kore motuhake a Te Apārangi e tautoko ana i ngā tāngata o Aotearoa ki te hōpara, tūhura me te tuari mōhiotanga. Ka tuku pūtea mā ana kaupapa me te tuku whai wāhitanga akoranga ki ngā kairangahau, kaiako, ākonga kura, me rātau e pakiki ana ki te ao. Hei whakanui i ngā tūhuratanga o ngā kairangahau o Aotearoa, ka whakawhiwhia e Te Apārangi ngā mētara me te tohu Pūkenga, he manukura nō ō rātau wāhanga. Ka āwhina ēnei tohunga i te Apārangi ki te tuku
Heoi, ka taea e ngā rangahau taketake huānga, i te wā roa, te whakaputa i ngā painga pērā i ngā hangarau hou, ngā hua rānei e taea ai te mahi moni; ngā putanga taiao pai; te hāpai rānei i te hauora me te oranga mō te iwi o Aotearoa. Mā te Pūtea Rangahau a Marsden, kua haumi a Aotearoa ki tētahi ohu mahi kairangahau tino matatau nā rātau nei i poipoi i ngā pūkenga me ngā tikanga mahi e puta ai ngā ihu i roto i ngā tūmomo whakapātaritari hou o tēnei ao hurihuri. Ko ētahi atu whāinga o te Pūtea Rangahau a Marsden ko te hāpai ake i te kounga o ngā rangahau i Aotearoa; he tautoko i ngā mōhiotanga o te ao whānui; me te tautoko i ngā rangahau e mārama ai ki a tātau i Aotearoa nei, engari kāore e taea e ētahi ara pūtea, i ētahi atu whenua kē atu rānei.
Ka whakahaerehia e Te Apārangi ngā tukanga tono me te tīpakonga; he tautoko i ngā mahi a te Kaunihera me ngā pae whiriwhiri; he whai arotake aropā mātanga; he tohatoha takuhe e ai ki ngā tohu nui i whakaaetia; he tātari i te anga whakamua o ngā rangahau e ai ki ngā pūrongo auau me ngā toronga; me te arotake i ngā putanga me ngā hua o te rangahau whakamutunga. I whakaingoatia te Tahua ki te Perehitini o mua Te Apārangi o mua, a Tā Ernest Marsden CMG CBE MC FRS FRSNZ (1889–1970), nā ana rangahau i kauneke ai tō tātau māramatanga ki te hanganga ngota me te ahupūngao karihi.
tohutohu motuhake ki ngā tāngata o Aotearoa me te kāwanatanga mō ngā take e arohia ana e te iwi whānui. He whānui te kōtuinga mema me ngā hoa o Te Apārangi puta noa i Aotearoa me te pōhiri i te hunga e kaingākau ana ki ngā mahi a ngā tāngata o Aotearoa ki te hōpara, tūhura me te tuari mōhiohio kia whakauru mai.
Mō ētahi atu kōrero anō haere ki royalsociety.org.nz
The Marsden Fund was established 30 years ago to promote excellent research that has the potential to generate long-term benefits for Aotearoa New Zealand. The Minister of Science, Innovation and Technology appoints a Council of nine eminent researchers to guide the Government’s investments through the Marsden Fund.
The Marsden Fund is contestable, in that New Zealand’s leading researchers compete for the opportunity to explore their best ideas using rigorous research methods. Eight panels of experts review their applications, with independent input from international peer reviewers, and select the best projects in each subject area. The Marsden Fund Council, currently chaired by Professor Gill Dobbie FRSNZ, reviews the panels’ selections across all disciplines, and decides which projects to fund. Researchers can apply for three types of grants.
• Marsden Fund Council Awards, worth up to $3 million over 3 years.
• Standard grants, worth up to $960,000 for 3 years.
• Fast-Start grants, for early-career researchers, worth $360,000 over 3 years.
Ultimately, fundamental research has the potential, in the long-term, to generate benefits such as new technologies or products that can be commercialised; positive environmental outcomes; or enhanced health and wellbeing for New Zealanders. Through the Marsden Fund, New Zealand has invested in a highly skilled workforce of researchers who have developed expertise and techniques which can be applied to solve new challenges in a rapidly changing world. Other objectives of the Marsden Fund are to enhance the quality of research in New Zealand; to contribute to global knowledge; and to enable research which has a clear rationale to be done in New Zealand, but which might not be funded through other routes or in other countries.
The Royal Society Te Apārangi manages the application and selection processes; provides executive support for the Council and assessment panels; obtains expert peerreview; disburses grants according to the agreed milestones; assesses progress of the research based on regular reporting and site visits; and evaluates the final research outputs and outcomes. The Fund is named in honour of a past President of the Society, Sir Ernest Marsden CMG CBE MC FRS FRSNZ (1889–1970), whose research advanced our understanding of atomic structure and nuclear physics.
The Society is an independent not-for-profit organisation, incorporating New Zealand’s Academy for the sciences, technology, and the humanities. In 2023, the Society published a longterm strategy to 2042 which set out a vision for Aotearoa New Zealand to be guided and inspired by science and research. The Society defined its purpose as growing pathways of knowledge to enable science and research to be shared for the benefit of all.
The Society’s work advances education in science and technology, promotes public understanding of science and research, and supports scientists
and researchers through project grants, career grants, journal publications, guidelines, and other knowledge infrastructure. The Society also provides independent advice to New Zealanders and the government on issues of public concern.
The Society achieves its impact through a broad network of members and organisations around New Zealand. To celebrate the achievements of New Zealand researchers, the Society awards medals for research excellence, and elects Fellows and Companions who are leaders in their fields.
To discover more visit royalsociety.org.nz

The first competitive round for the Marsden Fund was in 1995, when 60 projects were selected from almost a thousand applicants to receive a share of $6 million. Astrophysicist and space scientist, the late Sir Ian Axford FRS FRSNZ was appointed by the Minister as the first Chair of the Marsden Fund Committee. Five panels of experts assessed proposals in different research areas: agricultural, medical, and life sciences; earth sciences and astronomy; mathematical and information sciences; physical sciences and engineering; and social sciences. The Royal Society of New Zealand was appointed to provide executive support to the Committee, which later became the Marsden Fund Council, comprising up to eleven eminent and active researchers.
An early newsletter noted that the Marsden Fund “places emphasis on research of an unprioritised and usually of a fundamental nature, on fostering and supporting excellent researchers, including young scientists, and on enhancing the international reputation and prestige of New Zealand science and scientists generally.”
The Fund, it said, “invests in scientific research of the highest quality and in the necessary human capital associated with such research, rather than purchasing specific research outputs, and its operation should be perceived in this light.”
From the outset, the Fund was managed according to international best practice for reviewing and selecting proposals, monitoring progress, and evaluating the outcomes of the research. Over the ensuing 30 years, successive Chairs, Council members, and panellists have refined these processes, with support from the Royal Society Te Apārangi, to maintain the highest possible standards.
In 1997, the scope of the Marsden Fund was extended to include research in the humanities. In 2001, the Fast-Start scheme was initiated to provide opportunities for emerging researchers. Grants were originally $50,000 per year for 2 years and 20 were awarded. Since then, 867 early-career investigators have been awarded Fast-Start grants to develop independent research programmes. The first Marsden Fund Council Awards were conferred in 2019. The Council recognised

The Fund “invests in scientific research of the highest quality and in the necessary human capital associated with such research.”
the need to facilitate large, interdisciplinary collaborative projects and to significantly expand research possibilities and ambition through new links between researchers and institutions.
Over 30 years, the Marsden Fund has invested in a range of research led by Māori, and research that investigates Māori history and culture, Māori Indigenous knowledge, and contemporary Māori interests and perspectives. The Fund’s Council has provided guidance and leadership. The late Professor Terry Sturm CBE was the first Māori member of the Marsden Fund Council appointed in 1997, and was followed by the late Professor Jonathan Mane-Wheoki CNZM in 2002, Distinguished Professor Linda Tuhiwai Smith CNZM FRSNZ in 2011, Professor Jarrod Haar FRSNZ in 2018, and Professor Chellie Spiller in 2022, along with Professor Jacqueline Beggs In 2003, Professor Mane-Wheoki developed a set of Māori responsiveness criteria to be used by the Council and panel members for assessment of research proposals. After the former Ministry of Research Science and Technology launched its Vision Mātauranga policy in 2005, the themes

of Vision Mātauranga were incorporated into the Marsden Fund. In 2019, the Council had the benefit of a wānanga with the late Professor Angus Macfarlane CNZM FRSNZ on mātauranga Māori, and subsequent wānanga have continued to further the Council’s understanding since then. Of the research funded over the decade from 2013, more than half of funded research projects have contributed to the government’s Vision Mātauranga policy either by contributing one or more of the following: economic growth through innovative and distinctive research and development; achieving environmental sustainability through iwi and hapū relationships with the taiao; improving hauora health, and social well-being; or exploring indigenous knowledge and science.


Sir Ian Axford
FRS Hon FRSNZ (1996–98)
In 2010, the late Professor Craig Cary, funded to study extremophiles in Antarctica, took the flag on its first field trip and it then travelled to many sites around the world
“The Marsden is our pre-eminent investigator-led research fund and is a crucial contributor to building an innovation-led economy and society.”
In 2015, the independent non-profit institute, Motu Economic and Public Policy Research, analysed all available data for the Marsden Fund, and assessed that public expenditure through the Marsden Fund has been effective in increasing the quantity and quality of research outputs.
In 2016, the Science and Innovation Minister, Steven Joyce, stated that “The Marsden is our pre-eminent investigator-led research fund and is a crucial contributor to building an innovationled economy and society”. In Budget 2016, the government approved a package tagged “Innovative New Zealand” which increased the Marsden Fund by 49% to $66 million over 4 years.
From 2020, the COVID-19 pandemic and the necessary public-health responses seriously

Professor Diana Hill
FRSNZ (1999–2005)
Dr Garth Carnaby
FRSNZ MNZM CNZM (2005–08)

Distinguished Professor Sir Peter Hunter
KNZM FRS FRSNZ (2008–11)
disrupted the work of many researchers. Laboratory closures, travel restrictions, and social distancing measures forced many researchers to halt or significantly modify their work, particularly in fields requiring physical access to facilities, fieldwork, or human subjects, or international collaborations. The pandemic also necessitated adjustments and delays to processes for assessment and evaluation of research proposals. The Society worked with researchers to plan around COVID-related delays and constraints, and to renegotiate contracts where necessary to extend deadlines, modify milestones, and adjust reporting requirements.
In December 2024, the Investment Plan and Terms of Reference for the Marsden Fund were changed. The updated documents specify that the Fund should be invested in research that has been designed to generate quantifiable economic, environmental, or health benefit to New Zealand, with half dedicated to proposals with potential for economic benefit. The panels of experts which make recommendations on proposals were reduced from ten to eight (disestablishing the humanities and social sciences panels).


Royal

Professor Dame Juliet Gerrard DNZM (2012–18)

Professor David Bilkey (2018–22)

Professor Gill Dobbie FRSNZ (2022–present)

Our timeline features a selection of key milestones for the Marsden Fund, and some of the research highlights that have flowed from Marsden Fund support.
Many outstanding researchers and excellent projects are not represented due to lack of space. It must also be acknowledged that the research achievements shown here have often benefited from other funding sources in addition to the Marsden Fund.
Vaughan Jones, Marston Conder and David Gauld establish the NZ Mathematical Research Institute to promote mathematical research through international connections
Elaine Reese receives her first grant towards her groundbreaking’studies on early childhood development

Geoff Stedman opens the C-II ring laser facility in Cashmere Cavern, Christchurch to capture the rotation rate of the Earth
Nature publishes groundbreaking research by Michael Walker on how migatory animals use magnetic fields for navigation
Robert McLachlan begins world-first development of genomic integration, to simulate large-scale complex systems
Jeff Tallon, leading a team at Industrial Research Limited, is funded to develop high-temperature superconductors, leading, 20 years later, to diverse commercial applications and a worldleading export business
Microlensing Observations in Astrophysics (MOA) collaboration uses observation techniques to discover celestial objects, including a red dwarf some 17,000 light years away
Scott Baker investigates genetic diversity in whales, dolphins and sealions, particularly native species such as Hectors Dolphins
Marsden Fund supports work increasing understanding of BoseEinstein condensation and contributes to the development of an atom laser
Neuroscience researchers from the University of Otago awarded their first grant to investigate potential dopamine treatments for Parkinson’s Disease
Geoff Krissansen advances potential for antibodies to be used to treat multiple sclerosis
Stéphane Popinet joins NIWA to study fluid modelling. Later his Basilisk software has phenomenal uptake and is used to model environmental systems, such as wind turbines and tsunamis 1994 1996
Minister of Research, Science and Technology
Simon Upton proposes a contestable fund for excellent fundamental research
First competitive round: 60 research projects selected for investment across 5 different panels
Valda McCann becomes the Fund’s manager
Humanities are included in the Marsden Fund
First site-visits to assess the progress of funded research projects
Marsden Cottage houses the Fund’s three staff
Marsden Fund Committee convenes first meeting
Ian Axford is appointed as its first Chair
The Marsden Fund’s first manager is Michael Prebble Fund management transferred to the Royal Society of New Zealand
Diana Hill is appointed Marsden Fund Chair
Don Smith becomes the Fund’s manager
Fast-Start category is introduced ($50,000 per year for 2 years) and 20 are awarded to early career researchers
Sir Paul Callaghan wins the prestigious Ampere Prize for work supported by the Marsden Fund on nuclear magnetic resonance imaging
David Penny receives the Rutherford Medal for contributions to theoretical biology, molecular evolution and the analysis of DNA
Anne Salmond wins Montana Medal for Non-Fiction for her book The Trial of the Cannibal Dog, based on anthropological and historical research
Colin Green builds on a serendipitous earlier discovery of a way to block cells from preventing wound healing, which is later studied as a potential treatment for spinal-cord and brain injuries, and eventually leads to clinical trials for diabetic macular oedema
Gary Housley identifies and characterises the nerves and chemicals which convey signals from the cochlea to the brain for hearing

Richard Blaikie is included in New Scientist’s timeline – A Brief History of Negative Refraction
Ian Witten’s Weka team wins several international awards and the Hector Medal for world-leading work on machine learning, data mining and digital libraries
Janet Wilmshurst, Atholl Anderson, Thomas Higham and Trevor Worthy establish the date of Polynesian settlement of New Zealand (no more than 800 years ago)
David Parry wins the Rutherford Medal for work on fibrous proteins which make up muscles, connective tissues, hair and skin
Murray McEwan wins the Pickering Medal for developing and commercialising highly sensitive gas detectors, based on interstellar chemistry
Mau Moko, by Ngāhuia Te
Michael Corballis uses neuroimaging understand to how the left and right sides of the brain specialise in different functions - the first largescale study of its kind
Simon Cox, at GNS Science, studies liquefaction in the wake of the 2011 Christchurch earthquakes
Melanie Johnston-Hollitt and team begin producing the largest, homogenous catalogue of cluster galaxy halos and relics ever undertaken
Jevon Longdell investigates how quantum computers can use superconducting circuits to store quantum information
Deidre Brown, Jonathan ManeWheoki, and Ngarino Ellis begin tracing Māori art from its Polynesian origins to present day, and later publish the award-winning Toi Te Mana
Sally Brooker’s nanoscale work on metal-containing molecules features in the Journal of the American Chemical Society
Arthur Grimes completes investigation into whether homeownership improves the wellbeing of individuals and neighbourhoods
Funding leads David Ackerley to breakthrough discoveries in bacterial enzymes and antimicrobial resistance by studying genes in dirt samples
Craig Cary funded to study extremophiles which live in Antarctica, and takes the Marsden Fund flag on its first field trip
10th anniversary of the Fund
Garth Carnaby is appointed Marsden Fund Chair
Dean Peterson becomes the Fund’s manager
Peter Hunter is appointed Marsden Fund Chair
Juliet Gerrard is appointed Marsden Fund Chair
Marsden Fund staff of eight moves into the new Royal Society Te Apārangi building
Marsden Fund Cottage at 9 Turnbull Street is demolished
Peng Du builds a mathematical model of the stomach to explore gastric functions
Elizabeth McDonald publishes findings on adult victims of sexual violence in criminal trials

Rangi Mātāmua embarks on Ko Matariki e ārau ana | The Gathering of Matariki tour across Aotearoa and Australia
Renate Meyer’s statistical work on gravitational waves contributes to first ‘photograph’ of a black hole
A 200-year old Māori sail, Te Rā, is analysed by experts in weaving and traditional knowledge, including Catherine Smith, Ranui Ngārimu, Donna Campbell who travel to the British Museum, London, for their research
Craig Stewart, from NIWA, installs a network of melt monitoring stations on the Ross Ice in Antarctica
Vic Arcus, Louis Schipper lead a team exploring how biological systems respond to increasing global temperatures
Charles Higham and Hallie Buckley produce landmark insights on prehistoric civilisation from archaeological exploration in Thailand
Paul Scofield and Vanesa De Pietri use neutron tomography, an astounding new technique, to virtually reconstruct ancient penguin fossils
Rod Downey wins the Rutherford Medal for his revolutionary research in mathematical logic and computer science
James Noble wins the prestigious DahlNygaard Prize in software engineering
20th anniversary of the Marsden Fund, the flag makes its way to research sites around New Zealand and the world
Mark Stagg becomes Director of Research Funding at the Society, with Peter Gilberd as Marsden Fund Programme Manager
Motu Economic and Public Policy Research assesses that the Marsden Fund has delivered positive benefits for New Zealand
Publication of Tuai, A Traveller in Two Worlds, by Alison Jones and Kuni Kaa Jenkins, based on historical research on education
Laura Revell and University of Canterbury world-first confirmation of microplastics in fresh snow in Antarctica
Harlene Hayne is honoured as a Companion of the New Zealand Order of Merit for her contributions to health and wellbeing through research examining memory in the context of human development
Justin Hodgkiss uses ultrafast spectroscopy to observe how melanin protects skin from UV radiation
Stephen Robertson wins Hercus Medal for research on genetic conditions in children and on equitable delivery of genomic medicine, particularly for Māori
Johanna Montgomery’s research reveals role of zinc in brain-cell communication in autism
Nature publishes discovery by Greg Cook and colleagues on how some bacteria extract energy from hydrogen in the air, with potential to accelerate development of methods to generate “clean electricity”
Te Rā, the Māori sail, is brought to New Zealand on loan from the British Museum to enable further research
David Bilkey is appointed Marsden Fund Chair
Rachel Averill becomes Programme Manager for the Fund
The Covid pandemic causes severe disruption, necessitating adjustments to assessment processes, research contracts and the funding round
Gill Dobbie is appointed as Marsden Fund Chair
Marsden Fund Council confer the first two Council Awards for large, interdisciplinary projects 25th anniversary of the Fund, with 125 research projects funded
30th anniversary of the Marsden Fund, marked with a panel discussion at Parliament to review the benefits generated by research over the years
memo-circle-check 26,672 research proposals submitted since 1998
Every application is reviewed by a panel of carefully selected experts against strict criteria
831 EXPERTS HAVE SERVED ON PANELS SINCE 1996
International experts review the applications INDEPENDENT PEER REVIEW
16,129
ANONYMOUS REPORTS WRITTEN BY pen-to-square
13,624
INDEPENDENT INTERNATIONAL REVIEWERS SINCE 2000
3,069 PROJECTS SELECTED FOR FUNDING ranking-star
2,197 Standard grants
867 Fast Start grants (for emerging researchers)
5 Marsden Fund Council Awards (for large, interdisciplinary collaborative projects) THE MARSDEN FUND HAS GENERATED: arrow-up-right-dots
POWERING A WORKFORCE OF OUR BEST AND BRIGHTEST
2,080 PRINCIPAL INVESTIGATORS
810 ASSOCIATE INVESTIGATORS
2,090 RESEARCH ASSISTANTS
4,440 POSTGRADUATE STUDENTS BY 2024 THE FUND HAD SUPPORTED THE FULL-TIME EQUIVALENTS OF:
2,160 POSTDOCTORAL RESEARCHERS
ADVANCING KNOWLEDGE AND EARNING GLOBAL RECOGNITION BOOKS book 419 award 20% OF THEM IN THE TOP 10% OF WORLDRANKED GLOBAL PUBLICATIONS
15,937 RESEARCH ARTICLES arrow-down


On Wednesday 7 August 2024, Hon Judith Collins KC, then Minister of Science, Innovation and Technology, hosted an event in the Banquet Hall at Parliament to recognise the contribution of the Marsden Fund in supporting excellent research.
Through keynote speeches and a panel discussion, we reflected on how the Marsden Fund drives world-class research in New Zealand, and the place of supporting and incentivising excellent researchers to work on their best and boldest ideas.
In her address, Minister Collins acknowledged the current and past Chairs of the Fund who have overseen its strategic development over the years, and thanked the New Zealand panellists, external experts and international reviewers who have
dedicated their time to the process, and the Royal Society Te Apārangi for its administration.
Minister Collins said she wanted to see a thriving science system as this, she said, is crucial to growing the economy and achieving better outcomes for all New Zealanders. She spoke of building the capability of our scientists to meet the changing needs of our nation, to support our existing industries, and to grasp new opportunities that haven’t been thought about. “I see real potential for New Zealand researchers in areas

such as space, aerospace, biotechnology, quantum technology, advanced materials and medical technology”, she said.
Minister Collins acknowledged the important role of the Marsden Fund in supporting early career researchers, priorities for a return on investment, and that regulatory changes in gene-technology would give scientists a “real reason to be here, and a real reason to stay in science.”
Current Parliamentary Commissioner for the Environment, Rt Hon Simon Upton PC, delighted the audience by stating that initiating the Marsden Fund, “remains the best thing I’ve done in public life”. He reflected on his time as Minister of Research, Innovation and Technology in the mid-nineteen nineties and the vision for a contestable fund for fundamental research.
“For the first time”, said Mr Upton, “government funding has been made available not on the basis that the research will be useful (though it may be), or that it will solve an urgent problem (though it could do), but on the basis of its ingenuity and the likelihood of generating some first-class science.”

Professor Emily Parker FRSNZ moderated a stellar Marsden Fund panel, comprising Professor Dame Juliet Gerrard FRSNZ, Professor Richard Newcomb, and Professor Chellie Spiller, who were prompted to choose favourite projects; notable mentions including Professor Vic Arcus’ work on the temperature dependence of enzymes, and revitalisation in te ao Māori as seen on Matariki and the Māori sail, Te Rā.
Through their examples, the panellists illuminated the myriad benefits and impacts they had seen over the thirty years, speaking generously of careers supported and thriving, the generation of international collaborations, and the world-class research achieved.
View highlights from the speeches and panel discussion Bit.ly/MF60-22



In its three decades of supporting investigator-led research, the Marsden Fund has been the catalyst for a catalogue of breakthroughs.
Take the time Marsden funding helped the late Professor Ken McNatty FRSNZ and other AgResearch scientists (inspired by a strangely productive Canterbury ewe) to reveal how fertility is partly influenced by proteins within the female egg. It proved a major moment in the field of reproductive biology and remains one of New Zealand science’s greatest successes.
Then there was the Marsden Fund grant that aided the Malaghan Institute’s Professor Mike Berridge and his team to make a world-first discovery about how mitochondrial DNA moves between
cells in melanoma and breast cancer. That threw open new doors for understanding cell-cell communication – and potential treatments for a host of bone marrow disorders.
Here we present a selection of stories about how the Marsden Fund has been a pivotal agent of change for New Zealand. Each one speaks to a whakapapa of research and the building of innovation and capacity through themes of collaboration, great ideas, and the necessary mosaic of funding that leads to downstream benefits for the country.


A Marsden Fund grant in 2001 was the first external grant the Antarctic Research Centre (ARC) at Te Herenga Waka—Victoria University of Wellington ever received, and it was pivotal in providing the first paleoclimate evidence that Antarctica’s ice sheets are vulnerable to climate change.
The grant was awarded to Professor Tim Naish NZAM FRSNZ, who was then working for GNS Science. At the time, ARC only had two full-time employees: Emeritus Professor Peter Barrett NZAM, FRSNZ, the Centre’s original director, who was part of the first international Antarctic drilling project in 1972, and Alex Pyne, driller and expedition manager.
Receiving the grant meant that Naish was able to make sense of data from the Cape Roberts Drilling Project. From 1997 to 2000, this initiative drilled Antarctic sediment cores to reveal the last time our climate was 3–4 degrees warmer. In 2004, Naish received a second Marsden Fund grant, this time to understand the stability of the West Antarctic Ice Sheet in a warming world.
This research helped pave the way for New Zealand’s involvement in the US$36 million Antarctic Drilling (ANDRILL) programme, which began in 2005 and continued until 2014. ANDRILL was a multinational drilling programme using an ARC-designed system, involving New Zealand, the USA, Italy, and Germany.
In 2006 and 2007, during drilling at the McMurdo Ice Shelf, scientists recovered the two deepest rock cores in Antarctica—1,285 and 1,138 metres beneath the sea floor—containing a climate history of the continent going back 20 million years.
“There was a whole new area of expertise leveraged off ANDRILL that was transformational,” says Professor Rob McKay, ARC Director. “It changed the way the world perceived the potential impacts of Antarctica ice-sheet melting on sea level in the coming decades-to-centuries, and New Zealand became known for our global leadership in Antarctic science.”
McKay had been a PhD student at ARC in 2005 on the ANDRILL McMurdo Ice Shelf project. His role in ANDRILL provided a platform for him to take on leadership roles within the International Ocean Drilling Project. This initiative has leveraged hundreds of millions of dollars of international research investment for scientific exploration in New Zealand and Antarctic waters over the past decade.
In 2006, the Joint Antarctic Research Institute was established between ARC and GNS Science to allow these organisations to align resources and target investment in Antarctic and related earth science

We now know that we are committed to an increase of around 20 m global sealevel rise if we keep global warming above 2 degrees. This was unknown in 2001,”
research, and in 2007 enabled the building of the National Ice Core Research Facility, led by Professor Nancy Bertler. NIWA joined the Joint Antarctic Research Institute in 2009.
These research programmes built a reputation for New Zealand’s leadership in Antarctic ice research and changed the way the world understands the impact of climate change.

The prestige of the ARC researchers has seen several become lead authors for the Assessment Report of the United Nations Intergovernmental Panel on Climate Change. These IPCC reports are the basis for international governmental response, such as the Paris Agreement. Naish and ARC Professor of Glaciology, Nick Golledge FRSNZ have both been lead authors for these comprehensive five yearly reports that bring together international research to assess the impact of climate change.
Critically, the acknowledged scientific excellence of the ARC team, alongside their experience of international partnerships, laid the foundation for the Sensitivity of the West Antarctic Ice Sheet to 2°C of warming (SWAIS2C) project. This is an ambitious international collaboration between nine countries and the International Continental Drilling Programme, leveraging operations and science funding of over $20 million NZD.
“We now know that we are committed to an increase of around 20 m global sea-level rise if we keep global warming above 2 degrees. This was unknown in 2001,” says McKay.
Today, the ARC is funded through a variety of international collaboration, philanthropic

donations, and MBIE Endeavour Fund grants focused on more direct benefits for Aotearoa New Zealand.
“Within the complex New Zealand researchfunding landscape, Marsden Fund grants play a critically important role. They allow for higher-risk science to be conducted, but this science is also foundational and can be truly paradigm-shifting,” says Naish.
Networks of collaboration and funding have been instrumental in building New Zealand’s reputation for excellence and leadership in Antarctic and climate science. This is most clearly demonstrated by Naish’s recent election as the Chair of the prestigious World Climate Research Programme, the international body that coordinates research into the climate system across nations and scientific disciplines for the Assessment Reports of the Intergovernmental Panel on Climate Change.
“It’s not the volume or quantity of grants that matters, it’s the timing. We wouldn’t be here without the Marsdens and the Rutherford Discovery Fellowships because they were pivotal in helping us leverage off other opportunities and to secure more long-term funding,” says Naish.

It’s been more than 15 years since the Canterbury earthquakes began a revolution in how we understand the way earthquakes affect Aotearoa New Zealand. Professor Brendon Bradley FRSNZ, Civil and Natural Resource Engineering lecturer and researcher at the Te Whare Wānanga o Waitaha the University of Canterbury, and others around Aotearoa New Zealand, have spent their entire careers working to understand ground-shaking and its impact on our homes and the built environment.

Unheard of 15 years ago, Bradley’s earthquake engineering research explains how what’s on the surface of the earth affects ground-shaking. Different kinds of shaking at different frequencies can cause vastly different effects on different soils. For example, relatively strong high-frequency shaking in the Christchurch earthquake of February 2011 created a lot of liquefaction and collapse of unreinforced masonry buildings, whereas the Kaikōura quake in November 2016 caused relatively stronger low-frequency shaking 60 kilometres away in Wellington, damaging multistorey buildings with precast concrete floors.
After the 2010-2011 Canterbury earthquake sequence began, Bradley received his first Marsden Fund grant to understand the role of different physical factors in ground-shaking, taking into account the three-dimensional nature of the earth.
The increase in ability of high-performance computers to cope with immense amounts of data and access to those supercomputers has also been vital. Bradley worked on that first Marsden Fund grant with Robert Graves, a well-respected earthquake modeller from the United States Geological Service.
“He was the one that ran some first calculations and spoon-fed me how to do it,” says Bradley. “More than a decade later, I’ve got five software developers in our team to keep the ecosystem working.”
Despite these advances, we cannot predict earthquakes. We can, however, forecast them. A seismic hazard forecast says how likely it is that ground-shaking caused by an earthquake will happen in a given area, over a given time frame.

New Zealand’s first National Seismic Hazard Model was the brainchild of Professor Mark Stirling (Ōtākou Whakaihu Waka University of Otago).
Stirling brought everything geologists knew about earthquakes in Aotearoa New Zealand into a singular model. The very first National Seismic Hazard Model (NSHM) was produced in 1998 and subsequently updated in 2002 and 2010, and was used to inform the 2004 Building Code.
Bradley’s engineering work was a part of the new NSHM, launched by GNS Science in 2022. Produced by more than 50 scientists, engineers and stakeholders working together for just over 2 years, it amalgamated nearly a million different models into one big shaking hazard forecast of potential ground-shaking.
The 2022 NSHM forecasts are used by government and others to estimate risk and to make riskbased decisions. Under the 2022 NSHM, seismic hazard increased almost everywhere in the country, compared to what we knew previously.
More than a decade later, I’ve got five software developers in our team to keep the ecosystem working.”
This is not unexpected, because of scientific and technological advances, including better understanding of the Hikurangi Subduction Zone and the Alpine Fault.
For designers, property developers, central government, and local councils, precision engineering informed by earthquake research really matters. Every building will perform differently depending on structural layout, the ground that supports it, construction materials, and how much damage the owners are willing to accept at different levels of shaking.
The current New Zealand Building Code requires a building designed to last 50 years to withstand shaking with a 10% likelihood of being exceeded in its lifetime. This doesn’t encompass a single earthquake right underneath a specific place, but all the shaking a building could experience in its location.
For the past 3 years, Professor Ken Elwood has been seconded as Chief Engineer (Building Resilience) to the Ministry of Business, Innovation and Employment and the National Emergency Management Agency. He is working to update the piece of the Building Code that takes account of seismic loading (or the standard of shaking expected in that building’s location in an earthquake), and was last changed in 2004.

Dr Camilla Penney (University of Canterbury), shown here with a research assistant, is building a synthetic catalogue of earthquakes and simulators to understand how faults are interconnected
“A significant update to the Building Code does not happen because of a researcher’s efforts or a few research papers, but because of a national consensus-building programme, with strong international support,” says Elwood.
Bradley’s second Marsden Fund grant, awarded in 2021, involves using supercomputers to rapidly iterate earthquake simulations and improve predictions further.
Elwood suggests that the impact of Bradley’s work will be far more influential in the future than it is today. Bradley himself is enthusiastic: “Whether you need to spend $5 billion on a new hospital or whether you can get it done for $3 billion makes a huge difference. If we can quantify what’s going to happen better and be smarter from an engineering perspective, then
Some of the most instrumental funding sources, from my perspective were definitely Marsden Grants and the Rutherford Discovery Fellowship, not so much in size, but in terms of the flexibility of that funding.”
we won’t gold-plate things that don’t need to be gold-plated,” says Bradley.
He’s thankful for the support: “Some of the most instrumental funding sources, from my perspective, were definitely Marsden Fund grants and the Rutherford Discovery Fellowship, not so much in size, but in terms of the flexibility of that funding.”
Bradley can see a relatively clear pathway to where earthquakes become just a temporary inconvenience to those of us in Aotearoa New Zealand, rather than something that causes devastation.
“That’s not to trivialise the situation, because the pathway may take 50-plus years, but it’s possible to imagine a future where they are just a nuisance,” says Bradley.



Aotearoa New Zealand has stand out research in ecology - our biodiversity, pollinator networks, and food webs – using new techniques and increasing our understanding of global warming on ecosystems and organisms.

According to Manaaki Whenua Landcare Research, one in every three mouthfuls of our food relies on animal pollination, primarily from insects and birds.
Social insect specialist, Professor Phil Lester (Te Herenga Waka—Victoria University of Wellington), is an expert in insect boom-and-bust dynamics. He and his team use applied entomology for control of invasive ants and wasps. For the past 5 years, they have been developing and testing an innovative new treatment to help honeybees (Apis mellifera)
The varroa mite (Varroa destructor) is an insect population on the increase. Around the world, this devastating parasite is weakening honeybee colonies by feeding on their fat stores and spreading harmful viruses.
Lester studies a novel gene-silencing approach for invasive ant and wasp populations. His innovative work has positioned his lab perfectly to research a treatment for varroa mites.
Gene-silencing doesn’t change DNA, instead turning off specific genes, preventing their expression and subsequent protein production.
In this work, they are collaborating with GreenLight Biosciences in the United States of America, which is registering its innovative RNAi-based Norroa treatment with the US Environmental Protection Agency. According to GreenLight, there are about 3 million commercial honeybee colonies in the USA, with an estimated worth of $15 billion.


Norroa prevents the mites from producing eggs, though the adult mites survive. Importantly, the bees in treated colonies remain healthy and unaffected by the treatment.
“If we want to grow our agricultural and horticultural industries, we need bees to do that, and bees that are in good shape. The Marsden Fund has helped develop expertise and the basis of this gold-standard pest-control management that targets one species without harming others,” says Lester.
Field trials in New Zealand and around the world have tested Norroa in real-world conditions. Excitingly, these studies have confirmed its effectiveness in controlling varroa populations, particularly in hives with low-to-moderate infestations. Bees treated with Norroa have fewer mites, performed well, and their colonies have high rates of survival.
As Lester reflected, “10 years is not very long to develop an entirely novel technology that has an impact on invasive pest management, which makes the research results all the more exciting.”
The Marsden Fund has helped develop expertise and the basis of this gold-standard pest-control management that targets one species without harming others,”
Professor Catriona Hurd asserts her grant was instrumental in seeding wider research on ocean acidification and seaweeds, and resulted in landmark publications for her and her team.
Hurd is now at the University of Tasmania but was at the Ōtākou Whakaihu Waka University of Otago when she received her Marsden Fund grant, and still works at a global and Australasian scale.
“The skills developed under the funding are now being used for marine carbon-dioxide removal projects, including ocean-alkalinity enhancement and dissolved-organic-carbon release from seaweeds and its role in the coastal carbon cycle. The national Ocean Acidification research theme has been active for more than 15 years now and continues to be world-leading in this important climate change topic.”
“The underpinning knowledge we gained on the responses of algae to ocean acidification and climate change has contributed tremendously to environmental health of coastal New Zealand.”
Hurd cites the Marsden Fund as fundamental to altering her career trajectory. “It gave me an opportunity to hire excellent people and students and run world-class projects that would have been very difficult otherwise... The project has led to a global network of colleagues all of whom retain contacts and collaborations in New Zealand.”
One Marsden Fund project in particular was picked by our former Prime Minister’s Chief Science Advisor, Professor Dame Juliet Gerrard FRSNZ, as a current favourite.
The large interdisciplinary project led by Professors Vic Arcus and Louis Schipper (both at Te Whare Wānanga o Waikato University of
Waikato), studies the ‘really weird’ way enzymes behave with temperature – or, to put it more formally, it explores the temperature-dependence of Earth’s biosphere over time and space.
They are interested in how enzymes speed up reactions at a molecular level. Arcus developed the macromolecular rate theory (MMRT) to explain how the rates of biological processes are influenced by temperature, particularly focusing on macromolecules like proteins and enzymes.
Of the many published findings generated by the team, two particularly excite Arcus and Schipper – one relating to a ‘tipping point’ for plant respiration, and an ‘inflection point hypothesis’.
Published in Science Advances, the landmark ‘tipping point’ paper has led to a global upsurge in interest in the role of temperature in photosynthesis and was widely picked up by the media.
The underpinning knowledge we gained on the responses of algae to ocean acidification and climate change has contributed tremendously to environmental health of coastal New Zealand.”




It shows how the efficiency of photosynthesis drops off above 18 degrees Celsius and that the carbon plants and trees store in their trunks and soils is vulnerable to release. The land carbon sink could reach a critical tipping point within the next 20-30 years.
Arcus and Schipper believe their ‘inflection point hypothesis’, published in Nature
Communications, has the potential to have the greatest long-term impact.
Chemical reactions speed up exponentially in warmer temperatures – the warmer it is, the faster the reaction. But reactions that involve an enzyme speed up for a while as temperature increases and then slow down, so enzymes generally have an optimal temperature for their activity. If the temperature is exceeded, then enzyme activity drops away quickly.

Left: Emeritus Professor Barry Scott FRSNZ (Massey University) made important discoveries in fungal-plant interactions
Right: Professor Jason Tylianakis FRSNZ (University of Canterbury) publishes on biodiversity loss and species interactions
“Our paper suggests that the inflection point on the temperature-rate graph for enzymes dictates where the optimum growth temperature for the organism will sit,” says Arcus.
“When temperatures reach a point where growth rates become uncorrelated, we suggest that a critical failure takes place, leading to a dramatic drop in organism growth rates at these temperatures.”
If Arcus and Schipper are correct, the paper may hold the key to understanding how plants and ecosystems will react to global warming, with huge implications for research and many exciting avenues for future investigation, such as engineering the thermal tolerance of organisms.


(Left to right) Dr Kevin Davies FRSNZ (Plant & Food Research), Professors Joanna Putterill (University of Auckland), and Richard Macknight (University of Otago) their studies could inform how crops respond to climate change and improve crop yields.

Researchers are discovering new ways to train or assist the immune system to fend off cancers and diseases.
“The immune system is so complex, and many molecular and cellular interactions have yet to be understood,” says Professor Ian Hermans (Malaghan Institute of Medical Research).
“But some of the biggest breakthroughs in immunotherapy have come from basic research.”
Hermans is fortunate to have seen the wins that can stem from Marsden-funded research. His group shed important new light on dendritic cells, which play a crucial role in anti-tumour immune responses.
Dendritic cells, explains Hermans, “can determine whether an infection has taken place, or if tissues have mutated and become cancerous, and then co-ordinate an appropriate immune response.”
The pioneering work showed how dendritic cells are involved in stimulating the activity of
T-cells, which we all rely on to fight off viruses and intracellular bacterial infections. It ultimately contributed to the now widely accepted view that no two dendritic cells are the same, with some being better at the specific task of stimulating T-cells.
“All of this has proven very useful information for designing vaccines,” he says.
For Associate Professor Bridget Stocker (Te Herenga Waka—Victoria University of Wellington), Marsden funding proved pivotal in pinpointing a molecule found to help our bodies mount a more effective immune response to vaccines.
Back in 2014, Stocker was eager to investigate a class of compounds found on the cell wall of M tuberculosis bacteria (the cause of TB), and particularly an immune-cell receptor within them called Mincle.
Throughout a fruitful, decade-long research programme, Stocker and team, in collaboration with Japanese molecular immunologist Distinguished Professor Sho Yamasaki, have shown how activating Mincle makes for a unique immune profile that can be harnessed for a range of vaccination settings.
A US biotech company now has a licence on one of the team’s patents, and Stocker and research colleague, Associate Professor Mattie Timmer (Victoria University of Wellington), are currently working towards vaccine development with the Switzerland-based Vaccine Formulation Institute (VFI), with the goal of getting the adjuvants into the clinic.
Victoria University of Wellington microbiologist Professor David Ackerley can attest to his own Marsden-funded journey from curiosity to success.
His research team’s work on NTR 2.0 – a breakthrough tool for studying degenerative diseases – was originally just a minor part of a 2019 Marsden Fund grant.
The project was originally focused on screening soil DNA to uncover genes that offer weak resistance to antibiotics, tapping into the vast genetic diversity found in thousands of bacterial species.
Using a technique involving a strain of E coli, Ackerley’s team was studying antibiotics including metronidazole, commonly used to treat urinary tract infections and other conditions.
When they found E coli wasn’t naturally susceptible to this antibiotic, they turned to an enzyme engineered by another team member, postdoctoral scientist Dr Abby Sharrock. Called nitroreductase, or NTR 2.0, this enzyme allowed the team to create a hypersensitive strain of E coli,
making it easier to study genes that could make bacteria resistant to the antibiotic.
They found that the applications for NTR 2.0 stretch well beyond bacteria.
In a moment of serendipity, as Ackerley’s team was working on metronidazole, at the same time Professor Jeff Mumm was looking at the drug in his own research at United States’ Johns Hopkins University.
Mumm, whose career has long focused on neuronal regeneration, had already envisaged a clever solution whereby a gene, encoded by an enzyme, could activate an artificial drug like metronidazole.
NTR 2.0 proved the solution that Mumm was looking for, and a study between the researchers found the enzyme could kill targeted cells with much smaller doses of metronidazole.


Many of those sidelines will lead nowhere, but sometimes, when you have a particular bolt of inspiration from amalgamating ideas, that might be exactly what is needed to come up with a totally new solution to a problem.”
The team have since deposited their tools in an open-access repository, where research groups can access them for studying degenerative diseases ranging from Alzheimer’s to diabetes.
“Several hundred groups around the world have already accessed these tools, so it’s exciting to think about all the different kinds of degenerative disease research that our work will be supporting.”
He saw NTR 2.0 as a powerful example of what researchers could achieve when enabled by Marsden funding to explore all the “meandering sidelines” of research they were excited and driven by.

“Many of those sidelines will lead nowhere, but sometimes, when you have a particular bolt of inspiration from amalgamating ideas, that might be exactly what is needed to come up with a totally new solution to a problem.”
Microbiologist Professor Greg Cook FRSNZ has his own tale of Marsden-funded research leading to exciting opportunities for drug discovery.
An $825,000 grant awarded in 2016 allowed a team led by Cook and his Ōtākou Whakaihu Waka University of Otago colleague, Professor Kurt Krause, to delve into work that’s helped tackle antibiotic resistance and boost treatments for tuberculosis (TB).
Cook says the TB pathogen, M tuberculosis, is unrivalled in its ability to infect and kill humans – some 10 million people develop TB each year and 5,000 die from it each day – and it’s famously hard to study and treat.
But their study, which involved a team of international collaborators including Nobel Prize winner Professor Hartmut Michel, proved a major step forward.


It described, for the first time, the atomic structure of a key protein called bd oxidase, which lives inside the cell membrane of the TB bacterium and helps it to breathe under the low-oxygen conditions often found in TB-infected lungs. When the team knocked out this protein, they found the drug bedaquiline was able to kill M tuberculosis much faster.
Some new inhibitors have already been identified off the back of the work, with small animal trials now underway in a partnership between Otago and China’s Jinan University, and a global pharmaceutical company that drew on the seminal research for its own inhibitors.
Emeritus Professor Colin Green’s Marsden-Fundseeded science has followed a similar path from discovery to trial.
That began in 1997, when the ophthalmologist received a grant for a project focused on antisense oligonucleotides: small fragments of DNA that can bind to specific RNA molecules and stop them from being translated into proteins.
Green’s team at the Waipapa Taumata Rau the University of Auckland sought to learn whether these fragments could regulate cell-cell communication through specialised channels known as gap junctions, preventing production of a protein that blocks wound healing.
As Green and colleagues pushed the research further, they found their approach worked by regulating the body’s innate immune system, and that it had more promise for chronic conditions than for the initial target of treating acute wounds.
Two drugs, Nexagon and Xiflam, are now in midor late-stage clinical trials, with the latter being tested against diabetic macular oedema, agerelated macular degeneration, and long COVID.
“The work has built up more than 100 full research publications and reviews, more than 465 patents worldwide, multiple international collaborations and had added to New Zealand’s research standing on the world map,” Green says.
“And the whole story started with fundamental Marsden Fund research.”

New Zealand’s space sector grew by more than 50% in the 5 years to 2025 and contributed around 17,000 jobs and approximately $2.5 billion annually to the economy. Exposure to leading international programmes underpins much of this, with most New Zealand researchers having working relationships with companies setting up here.
Projects supported by the Marsden Fund are bringing cutting-edge technology to our shores and providing access to the world’s most sophisticated supercomputers. Software and modelling data being developed here is informing future space missions and providing insights in communication, climate, and space studies to fuel future growth in this sector.
One such cutting-edge project involves Professor Jenni Adams FRSNZ (Te Whare Wānanga o Waitaha the University of Canterbury) whose group is part of a collaboration between more than 350 scientists at 58 institutions around the world which operates the IceCube neutrino observatory.
Suspended from cables deep below the South Pole, this observatory uses more than 5000 optical sensors to detect neutrinos, observing our galaxy for the first time using particles instead of light.
The collaboration achieved a series of breakthrough results discovering astrophysical neutrinos in 2013 and identifying the first source of these neutrinos in 2017. Adams was part of the team to produce the first image of the Milky Way using neutrinos.
Statistician Professor Renate Meyer (Waipapa Taumata Rau the University of Auckland) has pioneered analysis of data from gravitational waves since the 1990s using techniques at the frontiers of physics and statistics to contribute
to Laser Interferometer Gravitational-Wave Observatories (LIGO). Meyer’s team collaborates with the European Space Agency and NASA as part of the Laser Interferometer Space Antenna Consortium.
An Ariane 6 mission is due to launch the spacebased Interferometer in 2035. It will be the first gravitational wave detector in space and will enable observations from sources with much larger masses than ground-based interferometers can detect, such as supermassive black holes at the centres of galaxies or the stochastic background from the early evolution of the Universe.
Meyer’s team contribute robust Bayesian nonparametric estimation algorithms and accurate numerical waveform simulations.
“Marsden Funding really made a world of difference,” says Meyer. “It provided the means to actively engage in international gravitational wave research of the LIGO Scientific Collaboration and to develop a network of collaborators in the USA and Europe. It not only provided a springboard for my own academic career but also for the careers of my PhD students.”
Other Marsden-funded research is revealing the secrets of the early Universe through the work of researchers like geochemist Stirling FRSNZ (Ōtākou Whakaihu Waka University of Otago) who revised the chronology of the early solar system, or Professor Richard Easther Auckland) who explores the origin and interaction of galaxies in the expanding Universe.
It
provided the means to actively engage in international gravitational wave research of the LIGO Scientific Collaboration and to develop a network of collaborators in the USA and Europe. It not only provided a springboard for my own academic career but also for the careers of my PhD students.”


Our ability to measure and observe space not only improves our understanding of what lies beyond, it provides knowledge applicable to our daily world. We now know more about solar forces, for example.
Associate Professor Jonathan Squire (University of Otago), says the surface of the Sun starts at 6,000 degrees Celsius, but over a short distance of only a few hundred kilometres, it suddenly heats up to more than a million degrees, becoming its atmosphere, or corona.
“This is so hot that the gas escapes the Sun’s gravity as ‘solar wind’, and flies into space, smashing into Earth and other planets.
“We know from measurements and theory that the sudden temperature jump is related to magnetic fields which thread out of the Sun’s surface. But, exactly how these work to heat the gas is not well understood – this is known as the Coronal Heating Problem,” he says.
Squire’s work on plasma, magnetic fields, and astrophysical systems like the solar corona and wind, critically improves our fundamental knowledge of this exotic but widespread form of matter. It lays foundations for understanding its turbulent behaviour and is yielding the first practical techniques for simulating such
Below:

plasmas, knowledge that is of interest to companies like OpenStar Technologies, a Wellington-based start-up building a prototype for a fusion reactor. Squire and University of Otago colleagues communicate and contribute to understanding around plasmas and solar activity, information that could be critical in an extreme solar weather event.
Technology initially conceived for space can have surprising applications. The Marsdenfunded research of Emeritus Professor Murray McEwan FRSNZ (University of Canterbury) was originally designed to investigate the ion chemistry of planetary atmospheres, instead it led to a fully developed commercial spectrometry solution.
Syft Technologies currently operates in seven countries and offers real-time, direct injection mass spectrometry to worldwide industries ranging from cancer screening and pharmaceutical development, to environmental protection, semiconductor manufacturing, and food flavours.
Other projects inspire wonder. NASA’s Dragonfly mission, which will send a rotorcraft to Saturn’s moon Titan, is scheduled to launch in July 2028 and is expected to arrive at Titan in 2034.




Among its quests it will investigate ‘co-crystals’, informed by the work of Dr Courtney Ennis (University of Otago).
Astrobiologists are predicting they will find multicomponent crystal minerals – co-crystals – which could facilitate chemical reactions to create biologically-important compounds like the elementary units of DNA.
Ennis and his team have established a laboratory which mimics the icy surface, atmospheric aerosols, and radiation environment of Titan. Under these conditions co-crystals are expected to form some of the organic chemicals necessary for life to develop. From this, Ennis’s team will be able to offer the Dragonfly mission some molecular clues as to what it will find.
New Zealand also has a niche in computational gravity – numerical simulations of gravitational systems. Researchers from the University of Otago Gravity Group, including Professor Jörg Frauendiener FRSNZ, Dr Chris Stevens and collaborators explore what phenomena can occur under Einstein’s theory of relativity by not only “tickling” but “punching” a black hole, effectively deforming it by shooting strong gravitational waves onto it and studying the reaction.
“There’s so much more to explore in Einstein’s theories. Most of the energy in research so far has gone on two black holes colliding, but there are other more interesting problems,” says Frauendiener.
While he admits it’s a rarefied field, it’s highly regarded internationally. Frauendiener is President of the NZ Association of von Humboldt Fellows and is proud that New Zealand attracts more Humboldt funding from Germany than any other nation per capita. He notes that there’s a very good story around career progression, and how all his PhD students go on to amazing things.
Career pathways into New Zealand’s space sector are underpinned by access to international research programmes. As well as providing new insights on space and the technologies that enable its observation, the Marsden Fund is investing in a home-grown workforce for international companies to establish here, either in the space sector itself, or related industries in communication, forecasting, and remote sensing.
Thirty years ago, Professor Elaine Reese FRSNZ from Ōtākou Whakaihu Waka University of Otago received her first Marsden Grant to look at language, self and memory in early childhood.

Professor Elaine Reese
This enabled her to recruit over 50 families for a twoyear study. The children were observed at 19 months and then again at 25, 32 and 40 months.
As well as assessing children’s non-verbal memory, Reese and her researchers also recorded mothers and children discussing recent unique past events, eliciting information about parental reminiscing style.
“We asked them to talk to their child about an event however they wished, for as long as they liked. There are huge individual differences in the way mothers talk with a barely verbal child,” says Reese.
Reese was awarded her second Marsden Fund grant in 1998 to examine the origins of autobiographical memory. “And lo and behold, the mother’s reminiscing style was important, but primarily for kids who had a strong self-concept going into it. Until children have a good solid self-concept, they’re not able to benefit from elaborative reminiscing,” says Reese.
This work led to Reese’s third Marsden looking at memory across generations and the construction of self. Reese thought that mothers who reminisce elaboratively with their children about emotional events were more likely to have a secure attachment style and so it proved.
By 2008, Reese had realised the importance of continuing to follow up with the children from her earliest studies as adolescents and young adults and the University of Otago funded her to keep the longitudinal study going.
“Here’s where the story really turns. We had over 150 kids who we have now followed up through to young adulthood. Adolescence is vital in developing identity and understanding how your early experience shapes who you are. That in turn is important for well-being, for life satisfaction, and self-esteem,” says Reese.


At around the same time, Reese received her fourth Marsden Fund grant to test cross-cultural differences in the life stories of young people from Māori, European and Chinese backgrounds. This study showed that the ability to reminisce about their lives was linked to wellbeing for 18 - 21 yearolds and was effective even earlier for Māori teens.
Living in Dunedin, Reese was well aware of the results of the internationally famous ongoing Dunedin Multidisciplinary Health and Development Study (the Dunedin Study). This study revolutionised understanding of how people’s early years have an impact on mental and physical health as they age. Particularly influential was a 2011 paper, which showed the level of self-control displayed in early childhood predicts health, wealth, and public safety more accurately than other measures such as intelligence or socio-economic status.
Professor Karen Salmon (Te Herenga Waka— Victoria University of Wellington) is a frequent collaborator with Reese. One of their key projects involved coalescing research on language development and self-regulation into an influential paper in 2016.
Language allows children to reflect over time, which has a positive effect on self-regulation. According to Salmon, language skills are vital in understanding other people and abstract concepts like emotions.
“Where children have poorer language skills it is harder for them to develop critical developmental skills, which go on to influence all future outcomes: health, wealth, and emotional wellbeing in adulthood.”
Reese built on this work, and that of Margaret Carr, Professor Emerita (Te Whare Wānanga o Waikato University of Waikato), who helped create the New Zealand early childhood curriculum Te Whāriki, to create the ENRICH programme. It is about strengthening teaching practice to promote reading, reminiscing, maths and sound-play.
In the early 2010s, colleague Professor Dione Healey (University of Otago) developed ENGAGE, a set of guided play activities that help hyperactive young children build their self-regulation at the right developmental time. She was funded by the Health Research Council, private foundations and the Ministry of Education.
In research trials with a diverse range of tamariki, ENGAGE showed significant and ongoing improvements in children’s self-regulation, with reductions in hyperactivity, aggression, and peer problems, and with improvements in their attention, effortful control, and emotional regulation.
ENRICH and ENGAGE were brought together in a national study to look at their impact in early childhood education.
In 2017, the late Emeritus Professor Richie Poulton CNZM, FRSNZ, then head of the Dunedin Study, was asked by the Wright Family Foundation to look into how teachers could promote children’s self-control or ‘self-regulation’. He had recently read the paper by Salmon and Reese that brought together research to show that language is vital in allowing self-regulation and was aware of Reese’s work on ENRICH as well as the work of Healey on ENGAGE.
Poulton and Reese and a team of researchers worked to design such a study, which started in 2021 using money from the Wright Family Foundation and the experience of Methodist Mission Southern in translating research into curriculum design. BestStart Educare, New Zealand’s largest provider of early learning centres, came on board as the vehicle for the study, providing access to over 130 centres and well over a thousand staff.
In 2024, Reese, along with Professors Justin O’Sullivan (Waipapa Taumata Rau the University of Auckland) and Vincent Reid (University of Waikato), and their international, interdisciplinary team were awarded the fifth Marsden Fund Council Award to address declining academic achievement and wellbeing among schoolchildren in Aotearoa New Zealand. This award, worth $3 million, allows Reese to follow up with children in their first two years of primary school to measure the impact on their education and socioemotional skills.
According to those assessing the award, this research “has potential to revolutionise childhood education on an international scale”.
When asked how Marsden funding of her work has affected Aotearoa New Zealand, Reese responded: “When I started doing this research it was a very intellectual fundamental science question – I could never have imagined that my blue skies social science research would have such long-reaching benefits. The new research shows that we can improve self-regulation across the board in toddlers. I know that if it can be used, we’ll see a more prosperous, healthy society, involving huge future savings.”

Language development from a young age. Supplied.


Professor Rebecca Campbell
Women’s reproductive health is bound up in fertility, but for researchers these days, it’s not only the ability for a body to become pregnant that is important, but how women’s lives and overall health are affected by medical issues such as polycystic ovary syndrome (PCOS), endometriosis, and menopause.
Research being conducted in Aotearoa New Zealand is offering some world-leading hope. The scientific understanding of reproductive ageing and the physiological differences between the sexes is gathering pace, and our researchers are at the forefront of making new discoveries to improve women’s health and fertility globally.
Marsden Fund grants, along with other research funds, such as the Health Research Council (HRC), are supporting our neuroendocrinologists to understand everything from the cellular physiology of PCOS and endometriosis to the psychology of pregnancy cravings and how they impact health later, to identifying which neurons cause hot flushes during menopause.
For the past 15 years, Professor Rebecca Campbell, an international expert in neuroendocrinology and director of the Centre
of Neuroendocrinology (CNE) at Ōtākou Whakaihu Waka University of Otago, along with the specialist women’s health Campbell Lab team have been researching how networks in the brain coordinate to control reproductive function.
“We are interested in the hormone release that comes from the brain and then also how the brain responds to hormones that are produced in the gonads, in both males and females,” explains Campbell.
Her research speciality is in understanding the role of this brain network in the development and treatment of PCOS, the leading cause of infertility in women.
Campbell came to Aotearoa New Zealand from the USA in 2002 on a Marsden Fund grant to work with Professor Allan Herbison FRSNZ, the first director of CNE, which was founded in 2003.

Since receiving her initial Marsden Fund grant in 2010, Campbell was awarded subsequent Marsden Fund grants in 2015, 2017 and 2023 and a large HRC grant with Professor Greg Anderson (University of Otago) and Professor Christine Jasoni CRSNZ (Te Whare Wānaka o Aoraki Lincoln University). These and other collaborative grants from the Marsden Fund to Anderson, Associate Professor Mike Garratt (University of Otago) and others have supported the research to branch out from decoding and modelling the role of neurons in PCOS to understanding how the reproductive process influence health and subsequent ageing.
The success of this research programme alongside the shift to focus on better understanding women’s reproductive health has led to a cascading effect in funding. As the reputation of the Campbell Lab and CNE grew, so too did the funding from local and international sources.
These funding injections also fostered the growth of women’s reproductive health research more broadly across Aotearoa New Zealand. Alongside PCOS, today’s researchers are also directing the world’s understanding of endometriosis and pregnancy health, and how these interplay with women’s fertility.
Professor Dave Grattan, Dr Rosemary Brown, and Dr Kristina Smiley
Simultaneously, there has been an increased global focus on women’s health. In 2019, the Buck Centre for Healthy Ageing Women opened in California. It is one of the first dedicated centres for women’s health in the world.
Just a year later, in 2020, the Maurice Wilkins Centre, a Centre of Research Excellence (CoRE), shifted focus in its metabolic health theme to include a focus on women’s health and PCOS, supporting the next generation of women’s health researchers. This theme is led by Professor Dave Grattan FRSNZ and Professor Peter Shepherd FRSNZ from Waipapa Taumata Rau the University of Auckland, with Campbell as a Principal Investigator.
In 2021, two researchers based at the CNE and associated with the Maurice Wilkins Centre received Marsden Grants to understand more about pregnancy health. Dr Rosie Brown researched how brain circuits control maternal behaviour, while Dr Sharon Ladyman (both of University of Otago) investigated how the manipulation of the pregnancy hormone prolactin may regulate body temperature, leading to healthier pregnancies.

An important piece of research that laid the foundation for the explosion of interest in reproductive research within Aotearoa New Zealand, is the work Campbell and others have done into neuronal activity unique to PCOS and how it shapes fertility outcomes.
“We’ve learned much more about how androgens influence different areas of the female brain, including the hypothalamus, which controls reproduction and metabolism, and the limbic system, an area associated with mood disorders,” says Campbell.
This work into androgen actions in the female brain has seen the Campbell Lab approached by drug developers, with whom they have recently signed a commercial contract.
In the early 2020s, Campbell met Associate Professor Jane Girling, a reproductive biologist new to the University of Otago and
an endometriosis research specialist. They joined forces to study the intersection between endometriosis and PCOS.
Research inspired by Girling’s endometriosis work also continues in other ‘women’s health’ spaces, including Te Whare Wānanga o Waitaha University of Canterbury researcher Dr Rachael Wood’s research on understanding the cellular function of endometriosis.
A biochemical engineer, Wood’s earlier research found that endometriosis has similar invasive properties to hormone-driven cancers. A Marsden Fund Fast-Start grant in 2023 is now helping her and her team create models to understand how endometriosis tissue behaves at a cellular level.
It’s not just women’s reproductive health that is under examination, however. In 2023, Garratt, Campbell, and Anderson received an international grant from the Center for Healthy Aging in
Women in the USA to understand how age at puberty and reproductive scheduling can impact reproductive ageing.
Other researchers are involved in work to model and understand how hormones and the brain interact and what interventions may improve pregnancy health.
In 2023, University of Auckland researcher Associate Professor Alys Clark received a third Marsden Fund grant to continue testing the world’s first virtual pregnant uterus, a model she first started in 2014.
In the same year, Dr Teodora Georgescu (University of Otago) received a Marsden Fund Fast-Start grant to understand how fever might be suppressed during late pregnancy to protect a growing foetus. Meanwhile, her colleague Associate Professor Mei Peng was funded to work alongside Garratt on a pioneering longitudinal study into behavioural changes in pregnant women.
In 2024, Dr Jenny Clarkson (University of Otago) received a Marsden Grant to understand the role of neurons in hot flushes during menopause with the aim of reducing sleep disturbance. Prior to this Jenny was the co-principal investigator, alongside Dave Grattan, in an HRC-funded project that looked at menopause. This research forms the
You can focus on the uterus, but you can’t understand the uterus without knowing what the ovaries are doing, without knowing what the brain’s doing. You need to know what the vascular system’s doing, what the immune system’s doing, about other cellular processes”
basis of the Marsden programme Clarkson and her team are currently working on.
The reality is that this kind of medical research is expensive, especially for those researchers who are working with live mammalian cells.
“None of these outcomes we’ve talked about would be possible without the support of Marsden and other funding bodies that provide the resources and fund the talent in the lab,” says Campbell.
Just last year CNE lost its university funding and is currently being kept afloat by its members, including funding from HRC or Marsden, or joint funding from outside New Zealand.
Girling says the fact that Aotearoa New Zealand is a small country means the type of interdisciplinary research that she, Campbell, Garratt and Anderson have been carrying out is possible because of their ability to form collaborative networks.
“You can focus on the uterus, but you can’t understand the uterus without knowing what the ovaries are doing, without knowing what the brain’s doing. You need to know what the vascular system’s doing, what the immune system’s doing, about other cellular processes” explains Girling.
“All of these things are fundamentally important to the functioning of any individual organ because as humans we’re a whole with interacting bits.”
Donna Campbell and Ranui Ngarimu studying Te Rā the Māori Sail at the British Museum. Image: Supplied

One of the earliest projects to receive Marsden funding was Kimihia te mea ngaro (Search for what is lost), the digitisation of Māori language newspapers, a social history and content analysis of Māori language newspapers from 1840–1950s.
Few New Zealanders are aware that Māori language newspapers, comprising some 35 titles (approximately 20,000 pages), constitutes one of the richest, oldest, and most extensive indigenous-language archives in the world.
From the 1840s and into the twentieth century, Māori language newspapers were published by government, churches, Māori, and Pakeha philanthropists. They are rare as a long record of Māori language in print, vivid in picturing Māori society and New Zealand history, and remarkable for Māori opinion. But before digitisation they were little used.
With the Alexander Turnbull Library as the host organisation, and a research team led by the late Professor Ngāpare Hopa MNZM, Dr Jane McRae, and the late Jenifer Curnow, the MāoriLanguage Newspapers Project aimed to promote use of the papers and to reveal the varied information they offer.
One of the results was Rere atu, taku manu! (Fly out, my bird!), published by Auckland University Press, 2002. This book has 12 articles on various aspects of history, language, and politics, based on information from the newspapers.
In the traditional Māori world, tā moko, or facial and body tattoo, was part of everyday life. Everyone had some patterning on their skin. Men wore elaborate designs on their entire faces; women were usually less complex but elegant, and both sexes had extensive body work. After almost disappearing in the 20th century, the practice is now experiencing a powerful revival, with many young urban Māori displaying tā moko as a gesture of ethnic pride and identity.
Mau Moko: the world of Māori tattoo (2007) is the result of many years of research by a team based out of the Te Whare Wānanga o Waikato University of Waikato, including Professor Ngāhuia Te Awekōtuku CRSNZ, Professor Linda Waimarie Nikora FRSNZ, and Professor Ngarino Ellis. Early historical records and manuscript materials were used to review the history and technology of moko, and present day moko wearers and artists were interviewed. Community participation was an essential part of documenting the modern tā moko revival.
Mau Moko won a Montana book award in 2008 and a year later was selected as Māori book of the decade.
On 24 June 2022, Aotearoa New Zealand celebrated Matariki, our newest official public holiday - the first to recognise Te Ao Māori, and the first new public holiday since Waitangi Day was introduced in 1974.
Traditionally falling at the end of the harvest, Matariki was a time of abundant food and feasting. Matariki marks the Māori new year, and is a period of reflection and remembrance, celebration and festivities, and the promise of a new season. People all across Aotearoa New Zealand now gather to mourn lost loved ones, share kai, and celebrate.


Mātāmua has been widely recognised for his passion to engage the public in the interface between science and mātauranga Māori.”

Professor Rangi Mātāmua has been described as instrumental to that happening. His research originates from a 400-page manuscript - an astronomical record containing the names of 1000 stars and 103 constellations, and Māori practices, that was compiled by a father and son in Ruatāhuna between 1898 and 1933, at a time when many customs were ceasing to be practised due to colonisation. The son passed the manuscript on to his grandson, who later passed it on to his own grandson, Rangi Mātāmua.
Mātāmua has been widely recognised for his passion to engage the public in the interface between science and mātauranga Māori. This has included television shows, online and print publications, social media blogs, more than 100 public lectures, a museum exhibition visited by more than 100,000 people, and a best-selling Marsden-funded book Matariki: The Star of the Year written in both English and te reo Māori. His
In 2023, an extraordinary piece of Māori cultural heritage returned to our shores. Te Rā, the only known customary Māori sail known to survive, is an important part of our nation’s cultural heritage. It was woven from harakeke (flax) more than 200 years ago and held in storage for many years at the British Museum. The homecoming of this taonga was a deeply significant moment for many New Zealanders.
Revealing complex weaving technologies, Te Rā is a symbol of Māori skill, innovation and adaptation, and the importance of voyaging in Māori culture. Dr Catherine Smith of Ōtākou Whakaihu Waka University of Otago, Ms Donna Campbell of University of Waikato and Mrs Ranui Ngarimu gained Marsden funding to study Te
Rā, combining Māori weaving knowledge with innovative materials identification that provided insights into this unique object and the voyages that first brought people to Aotearoa New Zealand.
Te Rā was welcomed at a formal pōhiri at Christchurch Art Gallery Te Puna o Waiwhetū, 14th June 2023, then displayed at Tāmaki Paenga Hira Auckland War Memorial Museum. Originally scheduled to return to London in June 2024, the overwhelming public interest and engagement with the sail led to a loan extension until June 2026 by the Trustees of the British Museum.
Art historians Professor Deidre Brown Waipapa Taumata Rau the University of Auckland FRSNZ and Professor Ngarino Ellis, first received Marsden funding in 2012 to begin tracing Māori art from its Polynesian origins to present day.
Their research led to the 2024 landmark publication Toi Te Mana - a Māori art history, written by Māori. Over 600 pages, it follows the journey of Māori art from ancestral weavers to contemporary artists at the Venice Biennale.
Their research led to the 2024 landmark publication Toi Te Mana - a Māori art history, written by Māori. Over 600 pages, it follows the journey of Māori art from ancestral weavers to contemporary artists at the Venice Biennale.”
A key influence on Brown and Ellis, the late Professor Jonathan Mane-Wheoki CNZM was there with vision at the beginning of the book’s writing, contributing some chapters and strengthening resolve to connect the many strands of Toi Māori.
In many cases, says Brown, the research is only just starting, with Toi Te Mana representing an important beginning to a new Aotearoa art history.


Professors Ngarino Ellis and Deidre Brown at the Ockham New Zealand Book Awards 2025. Toi Te Mana won BookHub Award for Illustrated Non-Fiction
Makers unknown Te Rā c. 1770–1800. Harakeke, kererū, kāhu and kākā feathers, dog skin. On loan from the Trustees of the British Museum. © Whakaarahia anō te rā kaihau Te Rā Project. Photo: Cultural Heritage Imaging


At the heart of nanoscience lies a simple premise, to understand and manipulate things at the atomic scale. New Zealand has a storied history of nanoscience beginning with Lord Ernest Rutherford OM, FRS, FNZI and living on through research institutes like the MacDiarmid Institute for Advanced Materials and Nanotechnology, Te Whai Ao –Dodd Walls Centre, and Paihau – Robinson Research Institute.
Since its inception, the Marsden Fund has supported New Zealand’s greatest thinkers to follow their boldest ideas. In quantum physics and nanotechnology, this creativity is leading to fundamental knowledge and commercialisation.
With a nod to physicist Professor Richard Feynman’s famous 1959 lecture, we’ve shown “there’s plenty of room at the bottom” for us kiwis.
The first Marsden Fund Committee was intent on strengthening New Zealand’s competitive position in the field of quantum physics. From the very first funding round, investment was made in groups at Otago, Victoria and Auckland Universities.
In 2004, pioneer of Nuclear Magnetic Resonance (NMR) Microscopy, the late Professor Sir Paul Callaghan GNZM FRS FRSNZ (Te Kunenga Ki Pūrehuroa Massey University), won the prestigious Ampere Prize. The research he was recognised for had received a Marsden Fund grant in 1997 as part of the concerted quantum physics focus.
Callaghan also formed Magritek with fellow researchers in 2004. The company’s small-scale nuclear magnetic resonance and MRI imaging products are now sold all over the world. It’s a story that inspires many New Zealand researchers.
The Committee’s 1997 efforts also included a grant to the late Professor Dan Walls FRS, FRSNZ and his group at the Waipapa Taumata Rau the University of Auckland to explore the possibilities
of an ‘atom laser’. Finally, the biggest grant of the 1998 funding round was awarded to a major Te Whare Wānanga o Waitaha the University of Canterbury-based initiative in nanoscience and optical lithography. Led by Professor Simon Brown, and also funding Professor Richard Blaikie FRSNZ, it comprised four inter-linked projects and aimed to seed a comprehensive research effort and to provide New Zealand with a competitive edge in a fast-developing field.
These early directions paved the way for consistent grants in quantum physics and nanoscience –they have played a pivotal role in many significant insights and discoveries. Within the wider mosaic of funding, the Marsden Fund also supported the establishment of the research centres, and the investment in people and resources that has helped create such an innovation pipeline for New Zealand nanotechnologies.
Quantum physics research can be loosely divided into theoretical and experimental approaches, but often has elements of both.
Professor Joachim Brand (Massey University) and Associate Professor Mikkel Andersen (Ōtākou Whakaihu Waka University of Otago) have a

Marsden Fund grant for their mainly theoretical research triggered by an experiment in Andersen’s lab. They explore how the chaotic motion of atoms in a gas emerges when working with very few atoms, i.e. by using ‘optical tweezers’ to add individual atoms together, one-by-one.
“While this research question is very much driven by curiosity”, says Brand, “it is also important foundational work”. He thinks that highly accurate quantum sensors or better hardware for quantum computers might be developed with the results of this project.
Understanding the fundamental and theoretical behaviour of atoms provides a foundation for future technology, says Andersen. He has worked in research institutes all over the world and says countries that put a stronger emphasis on theoretical physics also have bigger tech industries. “If you don’t make the investment, you don’t get the outcomes.”




Professor Blair Blakie (University of Otago) is known for his ground breaking theoretical work showing that under certain conditions gases can form into stable droplets as liquids do. This has been confirmed experimentally by scientists in Germany and the findings published in Nature It’s an exciting discovery that opens the door to potential applications performing chemical reactions or making highly precise measurements of magnetic fields.
Working at a more experimental level, Professor Niels Kjærgaard (University of Otago) has built an ultra-cold atom machine which uses powerful laser beams to create clouds of potassium and rubidium atoms at temperatures of less than a millionth of a degree above absolute zero. This highly regarded work won the 2023 Hector Medal and follows the pioneering studies of our most famous scientist, Lord Ernest Rutherford.
Superconductivity is another amazing phenomenon at the nanoscale, whereby materials conduct electricity with no electrical resistance under specific conditions, like the extremely cold temperatures of liquid nitrogen, or even colder. Such cold temperatures have hampered the commercialisation of superconducting materials. In New Zealand, we are world leaders in higher
Superconducting is another amazing phenomenon at the nanoscale, whereby materials conduct electricity with no electrical resistance under specific conditions, like extremely cold temperatures. Such cold temperatures have hampered the commercialisation of superconducting materials.
temperature superconductors (HTS), thanks in part to Marsden Funding. Developments by Professors Jeff Tallon CNZM, FRSNZ, Bob Buckley, and Rod Badcock FRSNZ (all Robinson Research Institute) are crucial in realising the commercial potential of HTS, although more work is needed.
Tallon and Industrial Research Limited studied HTS compounds and their use in diverse sectors— health, transport, energy, mining and minerals processing, telecommunications and information technology, as well as in research.
Tallon’s work, frequently collaborating with Buckley, has led to companies like superconducting magnet manufacturer HTS-110 and contributed


to the science behind startup company OpenStar Technology, which leverages high-temperature superconducting materials to explore nuclear fusion.
Badcock’s research is already having commercial impact and he is bringing his expertise to OpenStar. He explores HTS solutions that could enable step-change increases in the powerdensity and efficiency of electric machines, such as high-speed trains, using superconducting motors and electric power distribution systems.
Another recent innovation is the use of organicinorganic hybrids in HTS. Dr Shen Chong (Robinson Research Institute) has spent more than a decade developing new organic-inorganic metal oxide layered hybrids with Tallon. Together with HTS-100 and other scientists, they have commercialised a system for determining the characteristics of superconducting wires.
Overall, the HTS work sets the stage for a new, widescale industry in all-electric aircraft and could revolutionise power systems, aerospace population, and clean energy.
Worldwide, the race is on to further develop ultrafast laser spectroscopy with its potential for printable plastic electronics, such as solar cells and biosensors.
Professor Justin Hodgkiss FRSNZ (Te Herenga Waka—Victoria University of Wellington) is having success on a number of fronts. His group invented ‘transient grating ultrafast fluorescence spectroscopy’ and has a detailed understanding of photocurrent generation in printable solar cells.
In 2022, Hodgkiss spun Advemto out of this research, providing advanced 2D molecular barcode readers. These enable clinical and pharmaceutical labs to identify hundreds of biomarkers simultaneously.
Hodgkiss is also known for world-first technology on how melanin protects skin from UV radiation. Eumelanin may guide the design of new optical components and sunscreens and may later be applied to a host of other biomaterials.
Professor Miro Erkintalo, Associate Professor Stuart Murdoch and Professor Stéphane Coen FRSNZ (all University of Auckland), are among those exploring quantum optics, and optical frequency combs in particular, with considerable achievement.
The trio developed a novel micro laser source capable of generating new optical frequencies tunable across the mid-infrared spectrum. While lasers are everywhere in the modern world, frequencies in the mid-infrared range are difficult to generate yet are needed for the sensitive detection of many chemicals. The group’s Marsden-funded invention is cheap, tiny and suitable for commercialisation. The ground-breaking results were published in Nature Photonics in 2019. Since then, other groups have succeeded in reproducing the results on different microresonator platforms, most importantly, in integrated photonic chip devices.
To achieve such high performance, Erkintalo, Murdoch and Coen collaborated closely with Professor Harald Schwefel’s microresonator lab at the University of Otago.
Schwefel, and others such as Associate Professor Jevon Longdell (University of Otago), are working on exciting developments in quantum devices and frequency conversion. They have created optical frequency combs of record efficiency that show potential to significantly improve the internet by reducing the power required to encode data and the information-carrying capacity of optical fibres.
Professor Eric Le Ru (Victoria University of Wellington) uses light to measure materials. He has developed a spectroscopy device that delivers accurate tests of liquids that were previously thought impossible. His company, Marama Labs, has raised investment to take its “hazy wine analysis” business and expand into pharmaceutical manufacturing and life sciences. “Early investors were from New Zealand, then very quickly from
They can become more sensitive and have different kinds of interactions—they might change the way they conduct electricity or interact with light. For us as scientists, it’s about exploiting those new properties that you don’t get at larger scales.”
the US and Ireland,” said Le Ru. “The wine angle was a good place to start because we had access to a lot of wineries in New Zealand, but it was never the end game. Surface-enhanced Raman spectroscopy has always promised to be quite big, but it's never really realised its promise in applications because making it work is hard. So it’s exciting to take it from the theoretical and to figure out that promise.”
Also exploring fluids, Associate Professor Natalie Plank (Victoria University of Wellington), works on biosensors to measure substances, such as blood glucose levels, with a wide range of potential agricultural, clinical, and environmental applications.
Plank is interested in developing energy efficient devices out of nanomaterials, including carbon nanotubes and graphene. Her research couples biological receptors, such as aptamers, or insect odorant receptors, onto nanomaterials to make ultrasensitive and selective sensors.
She says the whole point of working on the nanoscale is that certain materials behave in radically different ways than they do when they’re bigger.
“They can become more sensitive and have different kinds of interactions—they might change the way they conduct electricity or interact with light. For us as scientists, it’s about exploiting those new properties that you don’t get at larger scales.”
Plank is also Deputy Director for Commercialisation and Industry Engagement at The MacDiarmid Institute. She says the potential for growth in the nanotechnology industry is huge.
“In 2020, the global nanotech market was worth about US$1.6 billion, and by 2030 it’s predicted to be worth over US$30 billion.”


Professor Jadranka TravasSejdic incorporated Spot Check Technologies Ltd with Emeritus Professor David Williams (both University of Auckland) for detecting the DNA signatures of infectious and chronic diseases.
Scientists are looking to nanoscience to tackle some of the world’s most challenging problems. At the nanoscale, the exposed surface of a material increases, often leading to new physical properties, such as changes in melting point, magnetic permeability, chemical reactivity, or electrical conductivity, for example.
One such is Professor Nicola Gaston FRSNZ (University of Auckland), who focuses on the underlying structure of materials and her work gives us fundamental insights into how atoms behave in alloys and at the surface. Such insights are essential for any future commercialisation in nanocatalysis, where surface atoms carry out catalytic reactions.
Professor Jadranka Travas-Sejdic FRSNZ incorporated Spot Check Technologies Ltd with Emeritus Professor David Williams FRSNZ (both University of Auckland) for detecting the DNA signatures of infectious and chronic diseases. Her group is also developing novel polymeric materials that are stretchable enough for medical use but crystalline enough for electronic performance, but this, she says, “remains a challenge”.
Professor Wei Gao ONZM, FRSNZ (University of Auckland) has made significant contributions in thin films and coatings, light alloys and corrosion. He and his group discovered a simple method to produce “black titania”, which can collect energy by absorbing UV from sun light, dramatically improving the efficiency of solar energy.

Currently 8% of the world’s power consumption is used to run computers and these chips should help reduce power consumption”
Taking things a step closer to commercialisation, Dr Nathaniel Davis (Victoria University of Wellington and Te Whai Ao — Dodd-Walls Centre for Photonic and Quantum Technologies) has developed a solar panel that can effectively cut photons in half allowing for improved efficiencies. Having filed a patent authored by himself and a PhD student arising directly from the initial Marsden Fast-Start grant, Davis is now being mentored by commercialisation experts across New Zealand readying for launch.
Other quantum chemistry research dedicated to finding cheap, clean and sustainable energy sources is being undertaken by Associate Professor Anna Garden (University of Otago), for example via hydrogen evolution reaction. Her group is also looking to refine the Haber-Bosch process by which ammonia forms to improve efficiency and output for more environmentally friendly production.
In research looking for a similar outcome, Dr Mathew Anker (Victoria University of Wellington) has described the synthesis of a highly reactive lanthanide(II) hydride complex. If ammonia can be produced under these conditions, it will transform the worldwide economy of fertilisers.
The founder of New Zealand’s first ever nanotechnology company, Professor Simon Brown (University of Canterbury) works on neuromorphic chips, and has an ongoing interest in the wider ethical, social, environmental and health impacts of nanotechnology.
“This has the potential for a huge impact on the world, by providing a low-cost computer chip that uses self-assembled nanocomponents to build brain-like structures that naturally support new approaches for solving highly complex tasks, including pattern and image recognition,” explains Brown.
“Currently 8% of the world’s power consumption is used to run computers and these chips should help reduce power consumption,” he says.
“The Marsden Fund grant is absolutely crucial in enabling us to really push on with this work and show that we can do useful computing with our novel chips.”
New Zealand’s creativity in manipulating the atom is giving us an edge in developing nanotechnologies and leading to unexpected ways of solving global problems. Consistent investment in fundamental research is generating start-ups and commercialisations. The promise of a major break-through seems tantalisingly close, whether this comes from high-temperature superconductors, new energy sources, or solar panels.
The Marsden Fund has been there to help support and enable our research community to dream big about little things. Thirty years of fundamental science at the atomic level has already led to remarkable discoveries – what will the next three decades bring?


Research with the potential to revolutionise childhood education, novel solutions to the climate and energy crises, and innovative approaches to overcome antimicrobial resistance are among the topics supported by the Marsden Fund in the 2024 investment round.


The Marsden Fund invests in excellent research, enabling New Zealand researchers to pursue cutting-edge ideas. In this, the 30th anniversary year of the Marsden Fund, 113 grants were awarded for potentially groundbreaking ideas in the sciences, mathematics, engineering, social sciences, and humanities.
The fundamental research projects selected respond to a huge range of nationally and internationally important challenges. They will generate vital knowledge and contribute to the development of advanced skills and capability in New Zealand.

In 2024, one large, interdisciplinary project received a Marsden Fund Council Award –the fifth to be conferred since the award was established in 2018. An international team led by Professor Elaine Reese (Ōtākou Whakaihu Waka University of Otago), Professor Justin O’Sullivan (Waipapa Taumata Rau University of Auckland) and Professor Vincent Reid (Te Whare Wānanga o Waikato University of Waikato), aims to address declining academic achievement and wellbeing among schoolchildren in Aotearoa New Zealand via an ambitious longitudinal study. The team has been awarded $1 million (ex GST) per year for the next three years for this research, which has potential to revolutionise childhood education on an international scale.
The Marsden Fund awarded 69 Standard grants to established research leaders and their teams. Just over a third of the grants conferred this year are Fast-Start awards, designed to support exceptional early-career researchers to develop independence and advance their careers. Altogether, $75.82 million (excluding GST) is being invested in research across the three award categories.
Several funded projects will use gene technology to address issues in agriculture and human health. Two lay the groundwork for the production of stress-resilient crops by using genetic tools to delete key genes that relate to stress or circadian rhythms. Another will develop highly specific genetic methods of destroying specific cells and tissues, improving our ability to study disease and regeneration processes in the lab.
A number of projects grapple with the threat of increasing antimicrobial resistance. They aim to find solutions to this pressing public health issue by investigating how bacteria develop resistance, identifying new targets for antibacterial treatments, and discovering home-grown antimicrobials in our flora and fauna (in particular, native insects and tuatara).
Other research seeks novel solutions to the climate and energy crises, through the development of improved solar cells, design of “crystalline sponges” that can mop up methane, and optimisation of reactions that can transform organic waste into valuable fuels and chemicals.
Some projects also have their eyes on the stars – one leverages access to the world’s largest neutrino telescope to identify the origins of highenergy particles in the Milky Way, while others will study bacterial biochemistry in order to better identify signs of life on other planets.
Many of these projects have specific relevance for Aotearoa New Zealand, for example investigating the risk of national disasters, enabling biocontrol of invasive pests, and exploring facets of our unique culture, languages, and history.
In this anniversary year, we are excited by the potential of this latest cohort of projects to deliver truly excellent outcomes for all New Zealanders.”
Professor Gill Dobbie FRSNZ, Chair of the Marsden Fund Council, said this year’s projects are highly innovative and groundbreaking.
“The Marsden Fund has driven world-class research in New Zealand for thirty years. It supports and incentivises excellent researchers to work on their best and boldest ideas, leading to new knowledge, skills and global connections, with the potential for significant downstream impact for Aotearoa New Zealand. In this anniversary year, we are excited by the potential of this latest cohort of projects to deliver truly excellent outcomes for all New Zealanders.”
Competition for grants from the Marsden Fund is intense and follows a rigorous assessment process. The 2024 success rates for Fast-Start and Standard award applications were 12.1% and 10.6%, respectively, slightly lower than for 2023. The success rate for Marsden Fund Council Award applicants was 12.5%.
“Through the 30 funding rounds, we have continuously refined our assessment processes to ensure best practice. International peer-review means that these novel ideas have been tested on the global market and that the projects are of true world-class standard,” says Professor Dobbie.
Ko ngā rangahau takahuri i te mātauranga kōhungahunga, ngā hua rerekē ki ngā raruraru
āhuarangi me te pūngao, me ngā aronga auaha hei turaki i te parenga āraimoroiti ētahi o ngā kaupapa kua tautokona e te Te Pūtea Rangahau a Marsden i ngā haumi o te tau 2024.


E haumi ana Te Pūtea Rangahau a Marsden ki te rangahau tiketike, e taea ai e ngā kairangahau o Aotearoa te rapu i ngā whakaaro tino hou rawa.
I roto i tēnei, te huritau 30 o Te Pūtea Rangahau a Marsden, 113 ngā takuhe i whakawhiwhia mō ngā whakaaro hou rawa i roto i ngā pūtaiao, te pāngarau, te pūkaha, te tikanga ā-iwi, me te aronui.
E urupare ana ngā kaupapa rangahau arohaehae i tīpakohia ki ngā tūmomo whakapātaritari hira maha o te motu, o te ao hoki. Ka puta i ēnei ko ngā mōhiotanga hira me te tautoko i te whanaketanga i ngā pūkenga me ngā pūmanawa tiketike i Aotearoa.

I te rauna tuku pūtea o te tau 2024, kotahi te kaupapa pūkenga whitiwhiti nui i whiwhi i Te Tohu a Te Kaunihera o Te Pūtea Rangahau a Marsden – te tuarima kua tohua mai i tōna whakaaratanga mai i te tau 2018. E whai ana tētahi rōpū ā-ao e arahina ana e Ahorangi Elaine Reese (Ōtākou Whakaihu Waka), Ahorangi Justin O’Sullivan (Waipapa Taumata Rau) me Ahorangi Vincent Reid (Te Whare Wānanga o Waikato), ki te huri i te heke o te paetae mātauranga me te oranga o ngā tamariki kura i Aotearoa mā tētahi rangahau wā roa hao nui. Kua whakawhiwhia te rōpū nei ki te $1 miriona (kore GST) i te tau mō ngā tau e toru nei mō tēnei rangahau, ā, ka taea pea e tēnei rangahau te takahuri i te mātauranga tamariki i te ao katoa.
69 ngā takuhe Arowhānui a Te Pūtea Rangahau a Marsden ka whakawhiwhia ki ngā amorangi rangahau me ō rātau rōpū. Neke paku atu i te hautoru o ngā takuhe i tukuna i te tau 2024 he tohu Tīmata-Wawe, he mea whakatū hei tautoko i ngā kairangahau pūhou whakahirahira kia tū pakari ai rātau me te kauneke i ō rātau aramahi. Huihui katoa, $75.82 miriona (kore GST) kei te haumitia ki te rangahau puta noa i ngā wāhanga e toru.
He maha ngā kaupapa ka whakamahi i te hangarau ira hei whakarite i ngā raru i roto i te ahuwhenua me te hauora tangata. E rua o ēnei kei te whakatakoto i te tūāpapa mō te whakaputa i ngā ahumāra pakari mā te whakamahi i ngā utauta iranga hei whakakore i ngā ira e pā ana ki te ahotea, ki ngā karaka tinana rānei. Ka hangaia e tētahi atu ngā tikanga iranga tino tauwhāiti o te whakakore i ngā pūtau me ngā whēkau tauwhāiti, te whakapai ake i tō tātau kaha ki te rangahau i ngā hātepe mate me te whakarauora i roto i te taiwhanga.
He maha ngā kaupapa kei te whiriwhiri i te mōrea o te nui haere o te parenga āraimoroiti. Ko tā rātau e whai ana ko te kimi rongoā ki ngā raru hauora tūmatanui nui mā te tūhura i te āhua o te tipu o te parenga huakita, te kimi whāinga hou mō ngā maimoatanga āraihuakita, me te rapu i ngā āraimoroiti nō konei i te ao o Tāne (otirā i ā tātau ake ngārara, tuatara hoki).
Ka rapua e ētahi atu rangahau ngā rongoā rerekē ki ngā raru āhuarangi me te pūngao, mā te waihanga i ngā pūtau kōmaru pai ake, te hoahoa “pūngoru tioata” hei muku i te mewaro, me te arotautanga o ngā uruparenga hei takahuri pararopi ki ngā kora me ngā matū hira.
He tirotiro hoki ētahi kaupapa ki ngā whetū – ko tētahi he whakamahi i te karu whakatata neutrino nui rawa o te ao hei tautuhi i ngā pūtakenga mai o ngā korakora pūngao-nui i Te Ikaroa, ā, kei te rangahau tonu ētahi i te matūkoiora huakita kia pai ake te tautuhi i ngā tohu o te ora i ētahi atu aorangi.
He maha ēnei kaupapa e tino hāngai ana ki Aotearoa, hei tautuhi i te mōrea o ngā aituā ā-motu, te whakamana i te patu kīrea urutomo, me te hōpara i ngā āhuatanga o tō tātau ahurea ahurei, ngā reo, hītori hoki.
I ngā pūmanawa o tēnei kohinga kaupapa hei whakaputa i ngā hua tino hirahira mō te iwi whānui o Aotearoa.”
Hei tā te Heamana o Te Kaunihera o Te Pūtea Rangahau a Marsden, a Ahorangi Gill Dobbie FRSNZ, he tino auaha, hou rawa ngā kaupapa o tēnei tau.
“Kua toru tekau tau Te Pūtea Rangahau a Marsden e kōkiri ana i ngā rangahau tiketike i Aotearoa. He tautoko, he whakapoapoa i ngā kairangahau mounga kia whakapau kaha rātau ki ā rātau whakaaro tino rawe me te māia, e puta ai ngā mōhiotanga, ngā pūkenga me ngā hononga ā-ao hou, e tino whai hua ai pea mō Aotearoa ā tōna wā. I tēnei tau huritau, e hiamo ana mātau i ngā pūmanawa o tēnei kohinga kaupapa hei whakaputa i ngā hua tino hirahira mō te iwi whānui o Aotearoa.”
He kaha tonu te whakataetae mō Te Pūtea Rangahau a Marsden, ā, ka whai i tētahi hātepe aromatawai pakari. Ko ngā auau angitu o te tau 2024 mō ngā tono pūtea Tīmata-Wawe me te Arowhānui he 12.1% me te 10.6%, he āhua iti iho ki te tau 2023. Ko te auau angitu mō ngā kaitono ki Te Pūtea Rangahau a Marsden a te Kaunihera he 12.5%.
“Mā ngā rauna pūtea 30, kua whakapaitia haeretia e mātau ā mātau hātepe aromatawai kia pai rawa ngā tikanga mahi. Nā te arotake aropā ka puta ēnei whakaaro rerekē i ngā whakamātautau o te mākete ao whānui, ka mutu he taumata tino tiketike ngā kaupapa,” te kī a Ahorangi Dobbie.
Thirty years ago, Professor Elaine Reese (Ōtākou Whakaihu Waka University of Otago) was one of the first ever academics to receive a Marsden Fund grant. Since then, many of her longitudinal studies into the impact of memory creation in toddlers and children have received similar funding. Increased knowledge about the positive impact of language as a way to improve self-control (or ‘self-regulation’) in children combined with Professor Reese’s research are leading to changes in the way early childhood teachers and parents interact with children in their care.
Professor Reese, together with Professor Justin O’Sullivan (Waipapa Taumata Rau University of Auckland) and Professor Vincent Reid (Te Whare Wānanga o Waikato University of Waikato) have now received a Marsden Fund Council Award of $1 million (ex GST) per year for three years. They will lead an international team to address declining academic achievement and wellbeing among schoolchildren. The research increases
understanding of brain development and will follow children involved in previous studies in their first two years of primary school, to measure the impact of language and self-control enrichment on their education and socioemotional skills.
The study aims to find new strategies for teachers and policymakers, which could transform educational programmes locally and globally.




Cosmic ray particles can reach higher speeds and carry more energy than nearly anything in the known Universe. But where and how are they generated? Professor Jenni Adams FRSNZ (Te Whare Wānanga o Waitaha University of Canterbury) will use state-of-the-art detection methods to trace their convoluted paths through the galaxy and identify the objects that produce them.

High-energy, sub-atomic cosmic ray particles are constantly travelling through our galaxy, largely unnoticed except when they interfere with our electronics. Where and how these particles are generated have been considered “holy grail” questions in physics since cosmic rays were first discovered in 1912. Supernovae are one promising explanation but confirming this has been extremely challenging. The trajectories of cosmic ray particles through the Milky Way are deflected by its magnetic field, making it all but impossible to trace their journeys back to the source.
Professor Adams and her team have received a Marsden Fund Standard Award to identify galactic objects that can generate cosmic rays by acting as powerful particle accelerators. Their trick is to study not the particles


themselves, but their ‘messengers’ - gammarays and neutrino particles that are created when cosmic rays smash into interstellar gas clouds. The team has access to the world’s largest neutrino detector, IceCube, which consists of thousands of sensor arrays buried under the Antarctic ice. Only last year, an international team including Professor Adams proved that IceCube is now sensitive enough to detect neutrinos produced by collisions between cosmic rays and interstellar gas clouds. In this project, the team will identify gas clouds close to potential cosmic ray sources, and then use observations of cosmic ray ‘messengers’ to model the trajectories of cosmic rays through these clouds.
By bringing together unique expertise and leveraging access to international collaborations and state-of-the-art facilities, this team may finally be able to answer some of the most pressing questions in fundamental astrophysics.
‘Forever chemicals’ released from consumer products are dangerous to ecosystems and human health. Dr Shan Yi (Waipapa Taumata Rau University of Auckland) will use artificial intelligence (AI) to scan for interactions between these compounds and human proteins to understand why they are harmful and which alternative materials are safe.
From non-stick cookware to paints and dental floss, many every-day products owe their useful properties to the extraordinarily strong chemical bond formed by fluorine and carbon in per- and poly-fluoroalkyl substances (PFAS). The downside of these compounds is that they are so resistant to breaking down that they accumulate in the environment, food, and in our bodies. PFAS exposure has been linked to metabolic disorders and chronic diseases, but how exactly they cause harm is poorly understood.
In this Marsden Fund Standard project, Dr Yi and team will explore how PFAS compounds interact with proteins in the body and how this might impact human health. They will use AI to computationally predict how PFAS molecules physically interact with all human proteins, making use of existing proteinstructure databases. Interactions that look likely will be experimentally validated by expressing human proteins in the lab, where the team can confirm that binding occurs and investigate how different concentrations of PFAS molecules impact protein function. Knowing which proteins can bind to PFAS and what roles they play in the body will allow the team to make predictions about likely health impacts of exposure.
By identifying novel molecular interactions and critical knowledge gaps, this innovative research can inform management strategies for forever chemicals and predict which alternative industrial materials are safe. The findings will also redefine how we evaluate chemical safety, shifting the paradigm toward more effective ecotoxicological assessments.


Dr Soledad Perez-Santangelo (Waipapa Taumata Rau University of Auckland) will investigate how plants adjust their daily cycles in response to changing temperature, paving the way for gene technology to increase the resilience and sustainability of our crops.

As climate change disrupts global food systems, there is an urgent need to understand how plants respond to temperature fluctuations. Plants change their physiology throughout the day and flower at the right time of year thanks to their internal circadian clock, which is synchronised by daily external stimuli - mainly light and temperature. However, rising temperatures due to climate change are expected to disrupt the coordination between light and temperature cues, throwing off plants’ internal clocks and negatively impacting their performance. To mitigate these effects, farmers need crops that thrive in increasingly unpredictable environmental conditions.
Dr Perez-Santangelo and their international team have received a Marsden Fund Standard Award to study how thermal cues set the internal clock and alter the physiology of legumes, an economically important group of crop plants. They will identify and validate circadian clock genes in a legume known as barrelclover (often used in research). The circadian clock pathway will be genetically modified to see how specific mutations impact the plant’s physiology and behaviour under different temperature regimes. This research will give valuable insights into the inner workings of plant circadian biology. By identifying key genes that influence how plants respond to changing temperatures, the research will inform breeding and genetic-modification strategies that can be used to produce climateresilient crops. Ultimately, the research has the potential to mitigate the impacts of climate change on agricultural productivity and futureproof global food systems.

By weaving together Māori and Pākehā legal systems and worldviews, Professor Nicole Moreham FRSNZ (Te Herenga Waka—Victoria University of Wellington) will generate new ways of thinking about law and the status of the dead in contemporary Aotearoa New Zealand.
In the 2022 case Ellis v R., the Supreme Court confirmed that Māori customary law, or tikanga Māori, can inform the development of common law (the law developed by courts) in New Zealand. The Supreme Court’s recognition of tikanga alone was enough to make Ellis a groundbreaking case, but it also addressed a profound, under-examined question: to what extent does a person’s name and reputation continue in the world after they die, and how (if at all) should that continued presence be protected by law?
Professor Moreham, Mihiata Pirini and Natalie Coates have been awarded a Marsden Fund Standard grant to explore how common law and tikanga might be woven together to answer this question. Tikanga tells us that a person’s mana (prestige, dignity, reputation) transcends death, and is maintained by their whakapapa and whanaungatanga (lineage and relationships).
Professor Moreham and her team will hold wānanga to discuss how death transforms mana and impacts tikanga, and examine how Western legal cases centred around the deceased challenge the traditionally ‘individualistic’ nature of common law.
This innovative project will develop nuanced understandings of practices in common law and tikanga, and show how these two worldviews might be combined to best maintain dignity after death. In doing so, this collaborative work explores one of New Zealand’s great contemporary legal challenges: determining how Pākehā law and tikanga Māori could work together.

Mā te whiri tahi i ngā pūnaha me ngā tirohanga o te Māori me te Pākehā, ka whakaputa i te Ahorangi Nicole Moreham FRSNZ o Te Herenga Waka ngā tikanga whakaaro hou mō te ture me te mana o te hunga mate i roto o Aotearoa i ēnei rā.
I te kēhi Ellis v R. o te tau 2022, i whakaūngia e Te Kōti Mana Nui ka taea e te tikanga Māori te whakamōhio i te hanga i te ture (te ture i hangaia e ngā kōti) i Aotearoa. Nā te whakamana a Te Kōti Mana Nui i te tikanga i hira ai te kēhi o Ellis, engari i ara i tēnei tētahi pātai hira hou: e hia te roa e ora tonu ana te ingoa me te mana o te tangata i muri i tōna matenga, ka mutu me tiaki tonu te ture i a ia?
Kua whakawhiwhia a Ahorangi Moreham, Mihiata Pirini me Natalie Coates ki tētahi Tahua Marsden hei tūhura me pēhea te whiri tahi i te ture me te tikanga hei whakautu i tēnei pātai. E kī ana te tikanga ka ora tonu te mana o te tangata i muri i tōna matenga, ā, ka ora tonu i roto i

tōna whakapapa, whanaungatanga hoki. Ka whakahaere wānanga a Ahorangi Moreham me tōna rōpū ki te kōrero mō te takahuri o te mate i te mana me tōna pānga ki te tikanga, ā, ka āta tirotiro hoki rātau he pēhea te wero a nga kēhi Pākehā e pā ana ki te hunga mate i te aronga noa ki te tangata takitahi i roto i te ture.
Ka puta i tēnei kaupapa auaha ko ngā māramatanga o ngā tikanga o te ture me ngā tikanga, me te whakaatu me pēhea te whakakotahi i ēnei ao e rua kia tino mau ai te mana i muri i te matenga. Mā tēnei, ka whakarite tēnei mahi ngātahi i tētahi o ngā wero ā-ture hira onāianei o Aotearoa: te whakatau me pēhea te mahi tahi a te ture Pākehā me te tikanga Māori.

Perovskite materials have great potential for use in low-cost, highly-efficient solar panels. But their instability in real-world conditions mean they have limited operational lifetimes. Professor Tom Bennett (Te Whare Wānanga o Waitaha
University of Canterbury) will produce and characterise next-generation perovskite glass materials with the potential to solve this problem.

Perovskites are a special class of inorganic materials commonly found in nature. A new type of perovskite material - a hybrid of inorganic and organic materials - has enormous promise for converting light into useful products such as electricity. One of its most promising applications is in the production of perovskite solar cells, predicted to have a market worth of US$2.5 billion by 2032. However, hybrid perovskite materials have some fundamental issues that limit their potential. In particular, they are unstable and tend to break down when exposed to everyday conditions and weather. Stability can be improved by adding a stable coating of plastic or glass, but this doesn’t solve the underlying issue and can have long-term environmental impacts.
Professor Bennett and team have recently shown that hybrid perovskite materials can be melted to form glass, which have superior stability to their crystalline counterparts. In this Marsden Fund Standard project, they will produce a library of different stable hybrid perovskite glasses and then characterise their structures and properties in detail. To ensure that the glasses formed are stable, the team will employ a new technique that they have found prevents recrystallisation. They will also investigate whether they can produce hybrid perovskite materials that switch between crystalline and glassy states, which could be used for devices with ‘memory’.
This work will revolutionise the field of glass science by producing next-generation hybrid perovskite materials with improved properties and diverse potential applications. By solving issues with perovskite solar cell stability, this research could make a significant contribution to unlocking a 100% renewable-energy future.
Hot flushes often wake us from sleep, leading to long term health issues. Dr Jenny Clarkson (Ōtākou Whakaihu Waka University of Otago) is investigating what links hot flushes with wakefulness, potentially revealing new strategies for managing menopause.
Hot flushes are a common experience during menopause and can be debilitating. Aside from their obvious discomfort, hot flushes are also associated with sleep disruption, which can negatively impact our long-term health. Although we know that hot flushes are caused by declining production of estrogen in the ovaries, we still don’t know what connects them to sleep disruption in the brain.
Dr Jenny Clarkson and Associate Investigator Dr Rosemary Brown propose that hot flushes and disrupted sleep are connected by a neurotransmitter called serotonin. Serotonin promotes wakefulness and is proposed to be released onto “KNDy” neurons, a subpopulation of neurons thought to cause hot flushes. Using a mouse model of menopause, the team will use state-of-the-art methods to observe serotonin release onto KNDy neurons in the brain and correlate this with wakefulness and body temperature. They will then see if they can reduce the frequency of hot flushes and awakenings by treating mice with selective serotonin re-uptake inhibitors (SSRIs). SSRIs are a commonly prescribed antidepressant that reduce hot flush severity in some people experiencing menopause.
Menopause hormone therapy is currently the frontline treatment for hot flushes but is often poorly tolerated. This research could ultimately generate new therapeutic approaches for those experiencing menopause, improving their health and quality of life.


In this project, Professor Lisa Marriott and Dr Brian Tunui (Ngāti Awa, Ngāti Pūkeko, Te Arawa, Ngāti Mākino, Ngāti Hamoa), from Te Herenga Waka—Victoria University of Wellington, will explore how tax models that affirm Te Tiriti o Waitangi can be used to support a more just and equitable society for all New Zealanders.
Before 1840, Māori had the right and capacity to make binding decisions about the wellbeing of their tangata (people) and whenua (land). This right and capacity was affirmed in Article Two of Te Tiriti with Article One granting the Crown kāwanatanga (governorship). Taxation and tax-like practices are essential components of both kāwanatanga and rangatiratanga, allowing governments to raise the necessary revenue to provide services for the public. The current tax system does not honour Articles Two or Three of Te Tiriti, as it infringes tino rangatiratanga and historical promises of equity.
Taxation in Aotearoa New Zealand, then and since, has resourced the kāwanatanga space, while contributing to dispossession in the rangatiratanga space and gradually erasing Māori self-determination. The current tax system does not honour Article Two or Three of Te Tiriti, as it infringes tino rangatiratanga and historical promises of equity.
To date, no attempt has been made to devise a Te Tiriti-affirming tax system based on systematic research, and Māori voices have rarely been heard in Aotearoa New Zealand’s tax policy discussions. Professor Marriott, Dr Tunui and their team aim to rectify this by identifying and articulating alternative tax system models that affirm Te Tiriti. Working with the Matike Mai Aotearoa framework for inclusive constitutional transformation, they will inform these models by investigating cases of suspected historical wrongs implemented under the guise of legitimate taxation and historic and current relationships between Māori and tax.
This study builds upon international experiences with alternative taxation structures in the USA, Canada, Wales, and Scotland. These international case studies will help the team explore possibilities that could inform Te Tiritiaffirming tax models. A tax system that affirms Te Tiriti will help to advance the relationships Māori ancestors envisaged in 1840.

I tēnei kaupapa, ka tūhuratia e Ahorangi Lisa Marriott rāua ko Brian Tunui (Ngāti Awa, Ngāti Pūkeko, Te Arawa, Ngāti Mākino, Ngāti Hamoa), o Te Herenga Waka, me pēhea te whakamahi i ngā tauira tāke e whakaū ana i Te Tiriti o Waitangi hei tautoko i tētahi iwi whānui tika ake, mana ōrite mō ngā tāngata katoa o Aotearoa.
I mua o te tau 1840, i te Māori te mana me te kaha ki te whakatau tikanga mō te oranga o ō rātau iwi me ō rātau whenua. He mea whakaū tēnei mana me tēnei kaha i raro i te Upoko Tuarua o Te Tiriti, ka mutu i raro i te Upoko Tuatahi i tukuna ki te Karauna te kāwanatanga. He wāhanga waiwai ngā tikanga tāke me ērā momo tikanga nō te kāwanatanga me te rangatiratanga, e taea ai e ngā kāwanatanga te kohi i ngā pūtea e hiahiatia ana hei tuku ratonga mā te iwi. Kāore e whakamanatia e te pūnaha tāke onāianei ngā Upoko Tuarua, Tuatoru hoki o Te Tiriti, i te mea he takahi i te tino rangatiratanga me ngā oati tuku iho o te mana ōrite.
Nā ngā tāke i Aotearoa, mai i taua wā ki nāianei, i whai pūtea ai te kāwanatanga, me te tautoko ki te tango i te rangatiratanga o te Māori me te whakakore i tōna mana motuhake. Kāore e whakamanatia e te pūnaha tāke onāianei te Upoko Tuarua, Tuatoru hoki o Te Tiriti, i te mea he takahi i te tino rangatiratanga me ngā oati tuku iho o te mana ōrite.
I tēnei wā, kāore anō kia tahuri ki te waihanga i tētahi pūnaha tāke whakaū i Te Tiriti i raro i ngā rangahau pūnahanaha, ka mutu he āhua kore nei e rongohia te reo o te Māori i ngā kōrero kaupapahere tāke o Aotearoa. Ko te whai a Ahorangi Marriott, Tākuta Tunui me tō rātau rōpū kia whakatikahia tēnei mā te tautuhi me te whakapuaki i ngā tauira pūnaha tāke rerekē e whakaū ana i Te Tiriti. E mahi ana me te anga Matike Mai Aotearoa mō te takahuritanga turepapa manaaki, ka whāngai mōhio rātau ki ēnei tauira mā te tūhura i ngā take o ngā hara o mua e whakapaetia ana i raro i te maru o te tikanga tāke tika me ngā hononga tuku iho, onāianei hoki i waenga i te Māori me te tāke.
Ka whakawhānui ake tēnei rangahau i ngā wheako o tāwāhi e pā ana ki ngā anga tāke rerekē i Amerika, Kānata, Wēra, me Kotirana. Ka āwhina ēnei mātai take o tāwāhi i te rōpū ki te tūhura i ngā arawātea hei whakamōhio atu i ngā tauira tāke whakaū i Te Tiriti. Ka āwhina tētahi pūnaha tāke whakaū i Te Tiriti ki te hāpai i ngā hononga i wawatatia ai e ō tātau tīpuna i te tau 1840.
Dr Matthew Scobie, Professor Adrian Sawyer and Rachael Evans




Associate Professor Ivy Liu and Professor Richard Arnold
Surveys provide critical population data that can be used to inform decisions in business, policy, healthcare and beyond. Associate Professor Ivy Liu and Professor Richard Arnold (both from Te Herenga Waka—Victoria University of Wellington), will develop new statistical methods for analysing surveys and extrapolating findings to the wider population.
Surveys are everywhere in modern life, from medicine to marketing - but the data we get from them are surprisingly difficult to work with. Surveys typically collect a range of different data types. For example, a medical survey might ask patients to record their height and weight (continuous data), age (ordinal data), and smoking status (binary or yes/no data), among other things. One of the most useful ways to analyse survey data is by sorting respondents into different groups (such as low or high disease risk) based on patterns in their responses, but this is statistically challenging when responses include different data types. It is also difficult to predict which of these groups someone falls into based on only partial data. Is there a way we can get more out of our survey data to make more informed policy and management decisions?
Associate Professor Liu and Professor Arnold have received a Marsden Fund Standard grant to address the statistical challenges of analysing mixed-data survey responses. They will create new general likelihood-based clustering methods to identify groups of survey respondents with similar response patterns. They will also build a model to extrapolate the findings

Survey respondents and survey questions are simultaneously grouped into clusters showing different response patterns
of mixed-data surveys to the wider population. Specifically, this model will use limited data from another source (for example, basic demographic data from GP visits) to predict which group a non-surveyed individual would fall into (for example, low or high disease risk).
By generating new methods for interpreting and extrapolating the results of mixed-data surveys, this research has potential to improve decisionmaking in areas like public policy, marketing, psychology and medicine.
Humans continue to produce more waste than the planet can reasonably sustain. In this project, Associate Professor Kelly Dombroski (Te Kunenga Ki Pūrehuroa Massey University) and a multi-sited team will investigate how community organisations help people work together to reduce waste.
An increasing number of people are concerned about waste and are trying to reduce, reuse and repair where they can. Conventional approaches to researching waste reduction try to get individuals to change their attitudes and behaviours, often focusing on actions like recycling. But this approach frequently fails to reduce waste, as most of us have little ability to change the wider systems that create waste in the first place. Instead of focusing on individuals, this research project asks how people act together to reduce waste and bring about collective change. How does involvement in community waste-reduction organisations affect people’s everyday habits and relationships? And how can people act together to create widespread social change that stops objects and materials becoming waste in the first place?
Associate Professor Dombroski, Dr Gradon Diprose (Manaaki Whenua - Landcare Research), Dr Matthew Scobie (Ngāi Tahu, Te Whare Wānanga o Waitaha University of Canterbury) and emerging researcher Lila Laird aim to answer these questions by investigating how collective action and community participation changes people’s relationships with stuff before it even becomes waste. Through collective inquiry groups and wānanga, the team will explore how organisations enable shared practices of waste reduction — including with the Zero Waste Network, Para Kore (a marae-based zero-waste initiative) and Repair Trust Aotearoa. In partnership with these organisations, the researchers will seek out examples of innovative waste-reducing practices and co-develop an
action plan to promote waste reduction in Aotearoa New Zealand.
This research will demonstrate how we can reshape the relationships between people, material goods, and the waste we produce. By informing more sustainable waste policies in Aotearoa New Zealand, this work could also help to avert the worsening global waste crisis.




Dr Danielle Middleton (Manaaki Whenua Landcare Research) hopes to solve the mystery of the tuatara’s remarkable Salmonella resistance – what can we learn from this at-risk relic to protect humans and other animals from disease?
As the sole survivors of an ancient line of reptiles, tuatara are one of Aotearoa New Zealand’s most unique taonga and a biological rarity. Dr Middleton and her colleagues have recently discovered that, unlike most reptiles, amphibians, birds and mammals, tuatara are also remarkably resistant to the highly contagious bacterium Salmonella. The team found Salmonella bacteria in tuatara burrows and infecting nearby lizards, but have never observed a single infected tuatara. What makes this species’ immune system so unique?
Dr Middleton and her team have received a Marsden Fund Standard grant to characterise the immune system of tuatara and identify the pathways that protect it from Salmonella infection. They will compare tuatara and other reptile genomes to see if tuatara possess unique
immunity genes, and test how blood samples of tuatara respond to infections using innovative immunological experiments. The team suspects that whatever makes the tuatara resistant to Salmonella may protect them from other infectious agents too. All work will be carried out with involvement and consultation from Ngāti Koata and Ngātiwai, who maintain a kaitiaki role over tuatara and the tuatara genome used for this research.
Salmonella is a widespread pathogen that infects nearly all vertebrate animals, and can cause serious illness in humans. By unlocking the secrets of our taonga, this research will broaden our understanding of the evolution of animal immunity, and may reveal new immune pathways or molecules that could be harnessed to improve animal and human health.

Using new statistical methods, historical censuses, and mātauranga Māori, eminent demographer Professor Tahu Kukutai FRSNZ (Ngāti Tiipa, Ngāti Māhanga, Ngāti Kinohaku, Te Aupōuri), from Te Whare Wānanga o Waikato the University of Waikato, will create the first statistical descriptions of Māori communities in 19th-century Aotearoa.
Tatauranga Aotearoa Statistics New Zealand held a census every five years under the Data and Statistics Act 2022. The collected data is useful for government, iwi, businesses, and the public to analyse and forecast social, cultural, and economic trends. This sensitive operation worked under strict rules and procedures, ensuring the generated data to be of sound quality. But this was not always the case.
Demographers studying population statistics in Aotearoa New Zealand have expressed particular concerns about the accuracy of Māori statistical sources during the 19th-century. This was a critical period of Māori population decline and research to date has relied heavily on flawed colonial censuses.
In this Marsden Fund Standard project, Professor Kukutai and her team will use a variety of approaches to correct for errors in these censuses. By combining novel statistical methods, critical analysis of the original census

records, and insights from te reo Māori sources, they will provide a more accurate account of 19th-century Māori demography. Their new methods and findings will be shared with other researchers, hapū and iwi through wānanga and development of user-friendly, open-source software.
Māori demographic history is a remarkable story of collective resilience – of coming back from the brink of around 40,000 in 1896 to nearly one million Māori in the 2023 census. The information gathered from this study will be crucial for our understanding of post-contact Indigenous depopulation, and how past events continue to shape the present. This worldfirst approach could also be applied to other countries to look back, and ensure that from now on, everybody is counted.

Mā te whakamahi i ngā tikanga tauanga hou, ngā tatauranga whānui o mua, me te mātauranga Māori, ka hangaia e te tohunga hangapori rongonui a Ahorangi Tahu Kukutai FRSNZ (Ngāti Tiipa, Ngāti Māhanga, Ngāti Kinohaku, Te Aupōuri), o Te Whare Wānanga o Waikato, ngā whakaahuatanga tatauranga tuatahi o ngā hapori Māori i Aotearoa i te rau tau 19.
Ka whakahaerehia e Tatauranga Aotearoa te Tatauranga Whānui i ia rima tau i raro i te
Ture Ngā Raraunga me Ngā Tatauranga 2022. He whaitake ngā raraunga ka kohia mō te kāwanatanga, ngā iwi, ngā pakihi, me te iwi whānui hei tātari me te matapae i ngā ia pāpori, ahurea, ōhanga hoki. Ka mahi tēnei mahi tapu i raro i ngā ture me ngā whakahaere pākaha, e whakarite ana he tino kounga ngā raraunga ka whakaputaina. Engari, kīhai i pērā i ngā wā katoa.
I puta ngā āwangawanga o ngā tohunga hangapori e rangahau ana i ngā tatauranga taupori i Aotearoa mō te tika o ngā pūtake tauanga Māori i te rau tau 19. He wā hira tēnei mō te heke o te taupori Māori, ā, i kaha whakawhirinaki atu ngā rangahau mai rā anō ki ngā tatauranga tātāmi hē.
I tēnei kaupapa Marsden Arowhānui, ka whakamahia e Ahorangi Kukutai me tōna rōpū i ngā tūmomo aronga hei whakatika i ngā hapa i roto i ngā tatauranga. Mā te whakakotahi i ngā tikanga tauanga rerekē, te tātaritanga arohaehae o ngā pūkete tatauranga taketake, me ngā kitenga mai i ngā pūtake reo Māori, ka puta i a rātau tētahi whakaaturanga tika ake o te hapori Māori o te rau tau 19. Ka tukuna ā rātau tikanga hou, kitenga hoki ki ētahi atu kairangahau, ngā hapū me ngā iwi mā ngā wānanga me te hanga i tētahi pūmanawa rorohiko māmā te whakamahi, tuwhera hoki.
He kōrero mīharo te hītori o te hangapori Māori e pā ana ki te tū pakari ngātahi – o te puta i Te Korokoro o Te Parata mai i te takiwā o te 40,000 i te tau 1896 ki te takiwā o te kotahi miriona te nui o te Māori i te tatauranga whānui i te tau 2023.
He mea hira ngā mōhiohio ka kohia mai i tēnei rangahau kia mārama ai mātau ki te heke o te taupori o te iwi taketake i muri i te taenga mai o tauiwi, ā, he pēhea te pānga o ngā āhuatanga o mua ki ngā āhuatanga onāianei. Ka taea pea te whakamahi i tēnei tikanga hou i te ao katoa ki ētahi atu whenua hei titiro whakamuri, me te whakarite mai ināianei haere ake nei, ka tatauhia te katoa.



Disorders of the digestive system affect more and more people, but their causes cannot be reliably diagnosed. Dr Recep Avci (Waipapa Taumata Rau the University of Auckland) will explore a non-invasive method to identify these diseases using bioelectric patterns on the skin.
Problems with the digestive system like persistent nausea or indigestion are on the rise. Chronic digestive disorders affect up to 10% of New Zealanders and place a considerable burden on the healthcare system. Treating these issues is difficult because they have various causes that cannot always be diagnosed by standard methods like blood tests or imaging.
Dr Avci has received a Marsden Fund FastStart award to explore a new, non-invasive method to identify the conditions that cause gastric diseases. The internal movements of the stomach wall are key for healthy digestion and are controlled by bioelectrical signals. Irregular electrical patterns in the stomach can cause disruptions to its function. The electrical fields generated within the stomach wall can be measured on the skin surface.
This project will develop a novel method to accurately characterise these fields, investigate abnormalities in electrical patterns on the skin, and trace them back to digestive disorders. The team will map the electric fields on the stomach and skin simultaneously to study how the electrical activities in the stomach are controlled, propagated, and expressed on the skin. As the transmission of the gastric electric fields to the surface will be influenced by the tissue between stomach and skin, this will be modelled for the exact body shape of the patient.
This research has the potential to revolutionise diagnostic methods through the monitoring of electrical activities. This could lead to better treatment options and improve the quality of life for patients in Aotearoa New Zealand and beyond.
DID A VIRUS SABOTAGE THE CONTROL OF ONE OF OUR MOST DAMAGING PASTURE PESTS?
Biocontrol offers several advantages over pesticides when it comes to combating invasive pests – when it works! Dr Sarah Inwood (Ōtākou Whakaihu Waka University of Otago) is investigating what caused a recent biocontrol failure and how to improve our chances of future success.



Invasive insect pests represent a significant threat to Aotearoa New Zealand’s natural environment and agricultural industry, costing around $2 billion a year in pasture damage. As increasing numbers of insecticides are banned due to their negative environmental impacts, biocontrol – using natural enemies to target pests –has become a popular alternative. Although it is more sustainable and environmentally friendly, biocontrol can be unpredictable, failing for reasons that we can’t fully explain.
Dr Inwood and her team have received a Marsden Fund Fast-Start grant to investigate the failure of biocontrol to combat the Argentine stem weevil, one of our most significant pasture pests. A parasitic wasp species was introduced to Aotearoa New Zealand in 1990 to control this species by parasitising adult weevils. These wasps were initially effective at bringing weevil numbers down, but over time, have become much less effective. Dr Inwood and her team recently discovered that the wasps here are infected by an undescribed virus, closely related to viruses that impact wasp behaviour. To determine if the virus might be linked to declining rates of parasitism, the team will compare historical and modern wasp samples to track virus spread and test its effects on wasp behaviour.
Revealing whether and how this virus impacts host wasps may allow us to regain control over populations of the Argentine stem weevil, saving the agricultural sector millions. More generally, this research should encourage safer and more effective design of biocontrol strategies that take hitch-hiking viruses and microbes into account.
A summary of the parasitic wasp’s life cycle and an image of a wasp larva emerging from the back of an adult Argentine stem weevil (figure credit: Peter Dearden)
INVESTIGATING THE EFFECT OF HEAT STRESS ON MITOCHONDRIA FROM HEALTHY AND DISEASED HEARTS
All human hearts are vulnerable to heat stress, and heat-induced heart failure will only become a more pressing issue as the planet continues to warm. In this project, Dr Amelia Power (Waipapa Taumata Rau the University of Auckland) will investigate the role of mitochondria in determining heat tolerance of healthy and diseased hearts.
Hot weather makes the heart work harder, increasing the energy required to keep it beating. Our heartbeats are usually powered by organelles inside of our heart cells called mitochondria, which use oxygen to convert chemicals from food into energy the cell can use. However, at very high temperatures, mitochondria become damaged or ‘leaky’, preventing them from generating the energy needed for heart cells to maintain our heartbeat. What determines the “critical temperature” when heart mitochondria fail, and how is this altered in people with cardiovascular disease?
In this Marsden Fund Fast-Start project, Dr Power will investigate how mitochondria in healthy and diseased heart cells respond to heat stress. They will use live heart tissue isolated from healthy patients and those with heart disease to
determine if diseased hearts are more sensitive to heat. Advanced microscopy techniques will then be used to examine what high temperatures do to mitochondria from healthy and diseased hearts on the nanoscale level. Finally, Dr Power will investigate whether drugs that stabilise the mitochondrial membrane could protect us from heat-induced heart failure.
The findings from this study will have significant implications for public health and cardiovascular health outcomes on a global scale. Although Aotearoa New Zealand is considered a temperate climate, extreme heat events are predicted to become more frequent and intense. As temperatures continue to rise globally, understanding the interplay between heat stress and mitochondrial function will be essential for developing effective countermeasures.

In this innovative project, Associate Professor Hinekura Smith (Te Rarawa, Ngā Puhi) of Pūrangakura Māori Research Centre will work alongside communities to explore the considered practice of traditional clothing making, and how it can contribute to positive Indigenous futures.
For centuries, traditional Indigenous clothing from Aotearoa New Zealand, Australia and the Pacific has been collected, catalogued and classified by early ethnographers intent on documenting ‘dying’ cultures and practices. However, this approach has often overshadowed the true significance of traditional garments - as vibrant cultural expressions that weave together history, identity, and community.
In this Marsden Fund Fast-Start project, Associate Professor Smith seeks to address this imbalance by shedding new light on traditional clothing making as a vital contributor to mental, spiritual and cultural wellbeing. Rather than simply viewing handmade textiles as exotic artifacts, this study will reveal the profound importance of traditional clothing making in transmitting knowledge, preserving traditions and fostering connection among communities.
Taking centre stage in this research project are the women working at revitalising practices of traditional clothing making today. As they create culturally generative garments, they simultaneously regenerate community activism, and pass on stories of language, culture, and identity.
As a weaver for over 25 years, Associate Professor Smith is herself embedded in the fibres of this work. Through wānanga, workshops,

and interviews, this practice-based research will generate new knowledge that will inform education, research, and wellbeing policies to enable Indigenous communities in Aotearoa New Zealand, Australia, and the Pacific to thrive through their own cultural practices.
I tēnei kaupapa, ka mahi tahi a Ahorangi Tuarua Hinekura Smith (Te Rarawa, Ngā Puhi) o Pūrangakura i te taha o ngā hapori ki te tūhura i ngā tikanga tuku iho o te hanga kākahu, me te āhua o te hāpai a tēnei i ngā anamata iwi taketake papai.
E hia rau tau, kua kohia, kua whakarārangitia, kua whakarōpūtia hoki ngā kākahu iwi taketake tuku iho o Aotearoa, Ahitereiria me Te Moananui-aKiwa, e ngā tohunga ahurea o mua i whai ki te hopu i ngā kōrero o ngā ahurea ‘e mate ana’ me ā rātau tikanga. Engari, i ngaro i tēnei aronga te tino hiranga o ngā kākahu tuku iho – hei whakaaturanga ahurea ihiihi e whiri tahi ana i te hītori, te tuakiri, me te hapori.

I tēnei kaupapa Tahua Tīmata-Wawe a Marsden, ka rapu a Ahorangi Tuarua Smith ki te whakarite i tēnei pōhēhē mā te tūhura i ngā kōrero hou mō ngā tikanga tuku iho o te hanga kākahu hei tino hāpai i te oranga hinengaro, wairua me te ahurea. Ehara i te mea ka tirotiro noa iho ki ngā papanga i mahia ā-ringatia hei taonga rerekē, engari ka tūhura kē i te hiranga nui o ngā tikanga hanga tuku iho o te hanga kākahu mō te tuku kōrero, te tiaki i ngā tikanga me te hāpai i te hononga i waenga i ngā hapori.
Kei waenganui pū o tēnei kaupapa rangahau ko ngā wāhine kei te whakarauora i ngā tikanga tuku iho o te hanga kākahu i tēnei rā. I a rātau e hanga ana i ngā kākahu ahurea, ka whakahaumanu hoki i te kaha o te hapori, me te tuku i ngā kōrero o te reo, te ahurea me te tuakiri.
25 tau a Ahorangi Tuarua Smith e mahi raranga ana, ā, he tohunga hoki ia ki ēnei mahi. I roto i ngā wānanga, ngā awheawhe, me ngā uiui, ka puta i tēnei rangahau ngā mōhio hou hei whakamōhio i ngā kaupapahere mātauranga, rangahau, me te oranga kia momoho ai ngā hapori iwi taketake i Aotearoa, Ahitereiria, me Te Moananui-a-Kiwa mā ā rātau ake tikanga.

Māori remember the earthquake that reshaped Te Whanganui-a-Tara Wellington’s terrain more than half a millennium ago. Dr Chris Rollins (Te Pū Ao GNS Science) will combine sophisticated geophysical analysis with mātauranga to determine how the Haowhenua earthquake occurred and what risks a repeat would pose for the region.
The first Māori settlers found Te Whanganuia-Tara a different place than the landscape we know now. One of the most striking examples is Te Motu Kairangi, or the Miramar Peninsula. When Māori arrived in the region, Te Motu Kairangi was an island - it only became a peninsula around 1460 AD when a powerful earthquake, the Haowhenua quake, thrust up the land bridge that now connects Miramar to the mainland. Despite the enormous significance of the Haowhenua earthquake, we are still lacking key geophysical data that would help us to predict and prepare for a repeat event.
Dr Rollins has received a Marsden Fast-Start award to investigate how this earthquake was triggered and how exactly it impacted the region. The team will collect detailed geological and geophysical data and run simulations to determine how large the earthquake was and which fault ruptured. Centuries-old mātauranga about the earthquake, passed down from those who experienced it first-hand, will be a key dataset. Specifically, the project will include wānanga with Muaūpoko iwi to discuss descriptions of the earthquake that appear in its name, in waiata and in local legends.
By weaving together sophisticated scientific analysis and stories of human experience, this project will advance our understanding of one of the country’s most legendary and destructive earthquakes. The more we know about disasters of the past, the better we can prepare for those of the future.
E maumahara ana te Māori ki te rū i huri i te āhua o te whenua o Te Whanganui-a-Tara neke atu i te rima rau tau ki muri. Ka whakamahia e Tākuta Chris Rollins (Te Pū Ao) i ngā tātaritanga matawhenua mātanga i te taha o te mātauranga Māori hei whakatau i pēhea te pā mai o te rū o Haowhenua, ā, he aha ngā mōrea mō te rohe ki te tūpono pā mai anō.
He rerekē te āhua o Te Whanganui-a-Tara ki tērā i kitea e ngā kainoho Māori tuatahi ki nāianei. Ko tētahi o ngā tino tauira hira ko Te Motu Kairangi. I te taenga mai o te Māori ki te rohe, he motu a Te Motu Kairangi - i ara ake hei kūrae i te takiwā o 1460 AD i te rū nui o Haowhenua, ka rewa mai te moana pāpaku e hono nei i a Te Motu Kairangi ki te tuawhenua. Ahakoa te tino hira o te rū o Haowhenua, kei te kuare tonu tātau ki ngā raraunga matawhenua hira ka āwhina i a tātau ki te matapae me te noho takatū mō tētahi rū pērā anō.
I whiwhi a Tākuta Rollins i tētahi tohu TīmataWawe a Marsden hei tūhura he aha te pūtake o tēnei rū, ā, he aha ake tōna pānga ki te rohe. Ka kohia e te rōpū ngā raraunga matawhenua o
runga me raro me te whakahaere whakataruna kia mōhio ai he pēhea te nui o te rū, ā, ko tēhea te ripa hapa i rū. He kohinga raraunga hira ngā mātauranga tuku iho mai rā anō i ngā rau tau mō te rū, he mea tuku iho mai i te hunga nā rātau i kite. Otirā, kei roto i te kaupapa ko ngā kōrero ka puta i te wānanga me te iwi o Muaūpoko hei kōrero mō ngā whakaahuatanga o te rū e kitea ana i roto i tōna ingoa, i rō waiata me ā rātau kōrero tuku iho.
Mā te whakakotahi mai i ngā tātaritanga pūtaiao mātanga me ngā kōrero a te tangata ka hiki i tō tātau mōhio mō tētahi o ngā rū rongonui rawa, tino tūkino hoki. Ka nui atu tō tātau mōhio ki ngā aituā o mua, ka takatū ake tātau ā muri ake.

Dr Chris Rollins doing campaign GPS fieldwork in Cook Inlet, Alaska
Dr Ruanui Nicholson, (Waipapa Taumata Rau the University of Auckland), will work with a team of computational mathematicians to build models that more accurately simulate how glaciers and ice sheets move. This research will help us prepare for the effects of rising oceans.
Ice flowing from ice sheets and glaciers into the ocean is a central contributor to sea level rise. Being able to model ice flow accurately is therefore crucial for predicting future sea level rise and resulting flooding. Generating accurate models of ice flow, however, is far from trivial. The data that feeds into our predictions of ice flow usually come from overhead satellite or aircraft measurements, which tell us about what is happening on the top surface of the ice but little about what is happening beneath. This leads to incomplete or missing data on some of the most important determinants of ice flow –for example, the shape and texture of underlying rock. Existing models do a poor job of estimating these features and how they influence ice movement.
Dr Nicholson has been awarded a Marsden Fund Fast-Start grant to develop new, accurate, and computationally efficient approaches to simultaneously model surfaces beneath the ice and their impacts on ice flow. Unlike existing approaches, the new methods will incorporate sources of uncertainty like the heat flux and thermal conductivity of ice. The models developed should be able to predict ice flow with greater accuracy and use less computing time and power than existing models. Sea-level rise is a global concern but is a particular threat to countries with low-lying coastal towns like Aotearoa New Zealand. Giving these communities certainty around sea-level rise will allow for better future-focused planning, and informed management of social and economic investments in areas such as tourism and fisheries.


Many of our country’s youth self-harm as a way of dealing with overwhelming emotions. Dr Kealagh Robinson (Te Kunenga ki Pūrehuroa Massey University) will explore how we can better support young people as they learn strategies to manage unwanted feelings.
One in four young people in Aotearoa New Zealand report deliberately injuring themselves – not to end their lives, but instead to cope with overwhelming emotions. Youth who self-harm have poorer mental health than their peers, are more likely to develop new instances of mental illness in the future, and are at increased risk of subsequent suicidal thoughts and behaviours. To reduce the frequency of self-harm and mental illness in youth, we need to support them to develop effective strategies to manage their emotions.

How can we better support young people who are learning how to deal with intense, disruptive emotions? Psychologists have shown that our beliefs about emotions, including how much control we have over them and how useful they are, shape our strategies when it comes to managing them. Tamariki learn many of these emotion beliefs at home from their whānau. In this Marsden Fund Fast-Start research, Dr Robinson and her team will investigate just how young people’s beliefs about emotion influence how they cope with strong feelings, and how this is shaped by their whānau. They will survey whānau and taiohi youth who self-harm as well as those who do not to understand how intergenerational learning might influence the likelihood of self-harming behaviours.
This research will answer fundamental questions about personal and social strategies that help us navigate a critical period of human development. Unravelling the influence of whānau on adolescent self-harm will also inform interventions to reduce its incidence and promote healthy coping mechanisms in our tamariki.
As antimicrobial resistance becomes more prevalent, we desperately need new drugs to combat bacterial infections. Dr Rory Little (Te Herenga Waka—Victoria University of Wellington) will explore the untapped potential of bacteria living on and in our native insects, to see if their chemical defences fit the bill.
Infectious bacteria are developing resistance to antimicrobial drugs at an alarming rate. Unless we can find a way to tackle resistance directly, we need to continue discovering and prescribing new drugs. Many of our most effective antibiotics are based on natural products that microbes produce to fend off competitors. Soil bacteria are particularly prolific producers of antimicrobials, but after decades of utilising this source, we have picked most of the low-hanging fruit. Are there other promising bacterial communities we could turn to for drug discovery?
Dr Little has been awarded a Marsden Fund FastStart grant to explore the untapped chemical potential of Aotearoa New Zealand’s insect symbionts, the bacteria that live on and inside our native insects. Some insect symbionts produce bioactive products that defend their hosts from infection, but this capability has not been explored in symbionts of our country’s own

unique insect species. After receiving approval from mana whenua, Dr Little and his team will collect a diverse range of native insects and screen their bacterial partners for antimicrobial activity. They will then sequence the genomes of the bacteria with the greatest potential for producing bioactive compounds. Candidate antimicrobials will be isolated and characterised in more detail.
By discovering new antimicrobial agents with potency against resistant bacteria, this research could contribute to a solution to one of the world’s most pressing public health challenges. The identified bioactive compounds may lead to improved outcomes for patients in Aotearoa New Zealand and worldwide, ultimately saving lives. Furthermore, the genome information will provide a foundation for future studies on bioengineering novel synthetic drugs and characterising enzymes that can be used in chemical industries.
Dr Rory Little
Summary of the workflow for this project. The central image shows agar plates with bacterial symbionts growing on them.
In this exciting project, Dr Reuben Collier (Ngāti Porou, Rereahu-Maniapoto) from Te Whare Wānanga o Awanuiārangi and a team of Māori language and broadcasting experts will analyse never-before-studied Māori audiovisual material to better understand the history of te reo Māori.
The last few decades have seen a resurgence in the recognition and use of te reo Māori in Aotearoa New Zealand, but more work is needed to ensure that this taonga truly flourishes. In particular, we need to ensure that regional dialects – which link iwi to their histories, geographies and cultural practices – are studied and preserved. Unfortunately, there are very few records that capture the history and spoken nuances of these dialects.
In this Marsden Fund Fast-Start project, Dr Collier and team will make a significant contribution to preserving and understanding the evolution of te reo Māori by analysing a previously unexplored Māori language resource. The team, composed of esteemed Māori language and media experts, has exclusive access to 400 hours of audiovisual footage from the ‘Ngā Tāngata Taumata Rau: Ngā Tamariki o Te Kohu’ documentary series. This archival footage features native speakers of the Tūhoe dialect, which has a number of unique language features due to the historical isolation of the Tūhoe people. The team will translate this footage and identify unfamiliar or uncommon language features (such as metaphors and gesticulations) and
examine dialogue, interpersonal engagement, and broader communication styles.
Through holistic analysis of this precious historical data, this research project will help to revitalise and preserve the diversity of te reo Māori, allowing it to be passed on to future generations. Its findings will also have broader relevance to our understanding of the evolution of language and culture.

I tēnei kaupapa whakaongaonga, ka āta tirotirohia e Tākuta Rueben Collier (Ngāti Porou, Rereahu-Maniapoto) o Te Whare Wānanga o Awanuiārangi rātau ko ētahi mātanga reo Māori, pāpāho hoki ngā kōrero ataata-rongo Māori kāore anō kia wetewetehia kia mārama ake ai ki te hītori o te reo Māori.
Kua kitea i ēnei tau maha nei te whakarauoratanga o te reo me te whakamahinga o te reo Māori i Aotearoa, engari arā atu anō ngā mahi e hiahiatia ana kia tino puāwai ai tēnei taonga. Otirā, me rangahau, me tiaki e tātau ngā mita – e hono ana i te iwi ki ōna hītori, rohe, tikanga hoki. Heoi, he itiiti noa ngā pūranga e hopu ana i te hītori me te hōhonutanga o ēnei mita.
I tēnei kaupapa Tahua Tīmata-Wawe a Marsden, he mahinga nui tā Tākuta Collier rātau ko tōna rōpū hei hāpai i te tiaki me te mārama ki te kunenga o te reo Māori mā te āta tirotiro i ngā rauemi reo Māori kāore anō kia āta tirotirohia. E whai wāhi ana te rōpū nei, he tohunga reo Māori, pāpāho hoki, ki ngā whakaaturanga ataatarongo 400 haora nō te rangatū pakipūmeka ‘Ngā
Tāngata Taumata Rau: Ngā Tamariki o Te Kohu’. Kei tēnei pūranga tahito ko ngā kaikōrero i te mita o Tūhoe, ā, he maha ōna āhuatanga ahurei o te reo nā te noho taratahi mai o te iwi o Tūhoe. Ka whakapākehātia e te rōpū ngā whakaaturanga me te tautuhi i ngā āhuatanga rerekē, kāore e tino rongohia rānei (pērā i ngā kupu whakarite me ngā hūkaritanga) me te āta tirotiro i ngā kōrero, te whanaungatanga, me ngā āhuatanga whitiwhiti kōrero whānui.
Mā te matawhānui o te tātari i ēnei raraunga tawhito, ka āwhina tēnei kaupapa rangahau ki te whakarauora me te tiaki i te kanorautanga o te reo Māori, e tukuna ai ki ngā reanga o muri mai. Ka whānui ake te hāngai o ngā kitenga ki tō tātau mārama ki te kunenga o te reo me te ahurea.
Dr Samarth (Te Whare Wānanga o Waitaha the University of Canterbury) and collaborators from Rangahau Ahumāra Kai Plant & Food Research will investigate how plants can sense sound vibrations through tiny hair-like structures on leaf surfaces. This research will lead to a better understanding of sound perception in plants and plant-environment interactions such as insect pollination.
Plants can detect sound vibrations from the environment and respond in ways that enable pollination, locate underground water, promote defence responses, and help adapt to stresses. But how do plants “hear” sound without ears? And how to they respond to different types of sounds?
In this Marsden Fund Fast-Start project, Dr Samarth will investigate whether tiny hair-like structures - or ‘trichomes’ - on plant leaves can sense sound vibrations and transmit signals from the leaf surface to inside the plant cells. Using a variety of imaging, molecular and electrophysiological techniques, Dr Samarth will compare responses to sound vibrations in
leaves that have trichomes with those that lack them in the model plant Arabidopsis. He will also investigate if plants respond differently to sound vibrations produced by insects that impact them in distinct ways (for example, bees buzzing and caterpillars chewing).
Understanding how plants ‘listen’ will improve our fundamental understanding of plant biology and ecology, but could also have practical benefits for agriculture. The research may reveal chemical-free ways of managing stress, optimising growth or promoting pollination of crop plants by providing specific auditory cues or manipulating plants’ auditory pathways.



On Thursday 16 May 2024, we marked the start of the 30th anniversary year with a gathering as part of our joint sponsorship of the Auckland Writers Festival with the Royal Society Te Apārangi. It was hosted in conjunction with the University of Auckland Faculty of Arts and provided an opportunity to recognise past panellists and convenors from the Auckland region.

The 2024 Festival was a tremendous celebration of the power of words. More than 85,000 people attended a week with over 200 events. The Society and Marsden Fund were proud to support three inspirational sessions – How To Survive Te Ara ki te Ora (with Airana Ngarewa, Nicola Toki, and Rob Mokaraka in conversation with Dr Emma Espinar), The Science of Science Fiction (with 3-Body Problem actress Jess Hong and Dr Octavia Cade in conversation with Associate Professor Geoff Willmott), and The Philosophy of Care (with US physician and author Dr Abraham Verghese, Professor Waikaremoana Waitoki and Hineatua Parkinson).
It was great to see Dame Anne Salmond FRSNZ recognised as the Auckland Writers Festival 2024 Honoured Writer. Fifty years of navigating te ao hurihuri in a fascinating career spanning conversation with Te Kawehau Hoskins. Ka rawe!

Top Left: Dr Octavia Cade, Jess Hong, Associate Professor Geoff Willmott
Bottom Left: Ariana Ngarewa, Nicola Toki, Rob Mokaraka, and Dr Emma Espinar
Right: Te Kawehau Hoskins and Dame Anne Salmond

RESEARCH IN FOCUS: Published 22 November 2024
Native ferns, sedges, and rushes have disappeared completely in some areas of Tongariro National Park, a new study finds.
Native plants in the Tongariro National Park are being hit hard by the spread of invasive heather with a 40 to 50 percent drop in native species in some areas, a new study has found.
“The expansion of heather is having a dramatic effect on native plant communities in Tongariro. In places where ground cover of heather is high, we found native ferns, sedges, and rushes have disappeared completely,” said study co-author Dr Julie Deslippe, a senior lecturer in Biological Sciences at Te Herenga Waka—Victoria University of Wellington.
Across the 15 sites surveyed in the study, areas with high coverage of heather had 11 fewer native plant species than those with low coverage, said Dr Deslippe.
Major changes in the growth of red tussock, a native grass and the dominant species in the national park, were also detected.
“We found a significant decline in the diameter of red tussock. We think the tussock may be responding to competition from the heather by reducing its spread and focusing instead on maintaining its height in an effort to survive.”
Heather’s expansion into the national park also appears to be having an effect below ground, said study co-author Darby Moyle, a Master of Science student at Te Herenga Waka.


“The roots of the red tussock play host to a particular type of beneficial fungus. The tussock and the fungus have a symbiotic relationship—each relies on the other for its survival. However, we discovered higher concentrations of heather were associated with lower levels of this fungus.
“We think this change is contributing to heather’s success and red tussock’s decline. The tussock is highly dependent on its symbiotic fungus so any reduction will make life harder for the tussock,” said Ms Moyle.
Heather has its own symbiotic fungus, which will spread as the plant advances. Heather is already common over roughly one third of the landscape in Tongariro National Park. The plant, with its distinctive pink flowers, is easy to spot from the Desert Road.
Heather was originally planted in the park in the early 20th century as part of plans to create habitat for grouse. It is now recognised as a pest plant and it is illegal to sell or distribute it.
“Heather’s invasion of our alpine tussock grasslands will likely lead to a loss of plant diversity, turning these native grasslands into low-diversity shrublands. We’ve seen similar patterns in other countries as invasive plants have made their way into mountainous areas, aided by a warming climate,” said Ms Moyle.
Results of the study are published in the journal Oecologia. The work, funded by a Marsden Fund grant, is part of broader research investigating how changes in alpine plant communities will affect the carbon cycle.
ADDITIONAL INFORMATION: Dramatic decline in Tongariro’s native plants as invasive heather spreads; VUW press release
ADDITIONAL INFORMATION: Julie Deslippe interview on Afternoons with Jesse Mulligan, Radio NZ

RESEARCH IN FOCUS: Published 2 August 2024
Researchers from the Ōtākou Whakaihu Waka University of Otago, Christchurch, have spearheaded the discovery of a protein function which has the potential to guide the development of novel cancer treatment options and improve the diagnosis of various cancers.
The exciting research finding was carried out by Dr Christoph Goebl, alongside Dr Vanessa Morris from the University of Canterbury’s School of Biological Sciences and researchers in Australia and Denmark, and centres on the activity of a tumour- suppressing protein called p16.
The discovery, published in the British scientific journal Nature Communications and first authored by University of Otago, Christchurch PhD student Sarah Heath, has shown that p16 has the ability to dramatically alter both its structure and its function.
“This discovery was a real surprise,” says lead researcher Dr Goebl, a Principal Investigator at Mātai Hāora – the Centre for Redox Biology and Medicine, in the campus’s Department of Pathology and Biomedical Science.
“We know that some proteins can be modified chemically to impact their structure and functions, but this is the first example of such a dramatic structural and functional change,” Dr Goebl says.
“We even found that it’s fully reversible – such dramatic changes were probably not believed possible until now.”
Dr Goebl says under normal conditions, the protein p16 protects cells from uncontrolled cell division. However, once it changes to what’s known as the amyloid (or dysfunctional) state, it loses this protective function.
“We found that the protein does its job perfectly when in the native state but loses all its abilities when in the amyloid state,” he explains.

Dr Christoph Goebl
“We currently think that this transition isn’t just a random process but likely a functional switch, and we were very surprised how black and white our results were regarding its function.”
Dr Goebl says his team made the discovery following many years testing p16 in the laboratory, using a combination of molecular and cellular experiments.
Once the protein is oxidised and in the amyloid state, it can be disassembled and “switched back to normal” by reversing its oxidation, he says. Therefore, the team was able to discover a redoxbased amyloid system which can switch between its normal state and the amyloid state by creating or breaking one chemical bond.
“The data looked almost too good to be true, but the more often we repeated our experiments, also with our collaborators overseas, the more confident we were that what we observed was real.”
Dr Goebl says p16 is amongst the top five proteins found to be mutated in various cancers, with the ability to actively cause certain types of cancer when damaged.
“Although this will be a future task for us to fully unravel, it could be that this amyloid transition plays a large role in cancer formation, and potentially also plays a role in the response to certain cancer therapies,” he says.
“This discovery has the potential to guide the development of novel treatment options and improved diagnostic procedures for various cancers.”
The Marsden Fund and Health Research Council of New Zealand (HRC)-backed study took fifteen researchers and four years to reach its conclusions.
With further support from the HRC, alongside fresh funding from the Canterbury Research Medical Foundation and the Cancer Research Trust, the team are now studying this structural transition and how it works in several different types of cancer cells.
“There are multiple avenues we are exploring, some range from using this novel knowledge to improve diagnostic procedures all the way to the development of new treatments that stabilise the protein in its native and healthy state,” Dr Goebl says.
This discovery could not have happened without support too from the people of Ōtautahi Christchurch, he says.
“We are very grateful that so many cancer patients here in Christchurch are very generously donating their tissues to the He Taonga Tapu Cancer Society Tissue Bank, which has supported our work so far and will continue to do so in future.
“I am confident that together with our collaborators in the USA, Canada, Europe and Asia we will be able to understand this new protein behaviour and turn it to our advantage for use in future potential cancer treatments.”
ADDITIONAL INFORMATION: New protein discovery may influence future cancer treatment: University of Otago media release
ADDITIONAL INFORMATION: Nature Communications paper (Heath et al, 2024)

RESEARCH IN FOCUS: Published 27 May 2024
Meet BabyX, a digital infant looking for someone to play with.
BabyX is a hyper-realistic computer-generated simulation of a human infant.
In a world first, developmental psychology researchers at Waipapa Taumata Rau University of Auckland will use the digital child to research adults’ interactions with babies.
The infant on a computer screen responds to a social partner – including their voices, gestures, and expressions – just as a human infant would, smiling, laughing, crying, or getting cross and frustrated.
The aim of the research is to look more closely at the nuances of communication between caregivers and infants.
“Decades of research has shown us that babies are incredibly responsive to even very subtle changes in where caregivers are looking, what they say and how they say it,” says Professor Annette Henderson, the director of the University’s Early Learning Laboratory. “However, very little is known about how changes in babies’ behaviour affects their caregivers’ responses – we aim to close that loop.”
Interacting with caregivers, infants learn about love, language, behaviour and forming connections, all vital for a healthy life. BabyX lets researchers look at those interactions in ways which wouldn’t be possible with a human baby.
“We can uncover how specific aspects of baby behaviour influence the interactive dance with their caregivers,” says Henderson. “Because human babies’ behaviour cannot be manipulated, answering this question has been impossible to do… until now.”
As a first step, Henderson and Research Fellow Dr Florian Bednarski are seeking 80 fathers, mothers or other primary caregivers of children aged 12 to 36 months to engage with BabyX in the lab at the University of Auckland. The caregivers will be recorded – confidentially – playing interactive digital games such as puzzles with the toddler.
(If you’re interested, email earlylearning.nz@gmail. com to register or call 09 923 4236.)
BabyX was developed by Associate Professor Mark Sagar FRSNZ, the University alum who is a leader in creating virtual humans, and Soul Machines, a spinoff from the University’s Auckland Bioengineering Institute.
Empowered by artificial intelligence, BabyX sees and hears via video and audio feeds, and processes the world through a simulated human brain. While BabyX was unveiled in 2017, this first research use takes place after Henderson and her team including Bednarski, Associate Professor Mele Taumoepeau (Te Herenga Waka Victoria University of Wellington) and Sagar (Soul Machines) received support from the Marsden Fund.
The ultimate aim is to help parents better care for infants.
ADDITIONAL INFORMATION: Digital infant in world-first psychology research, University of Auckland media release

RESEARCH IN FOCUS: Published 28 November 2024
Ōtākou Whakaihu Waka University of Otago's commitment to developing genomics capability with Indigenous Pacific communities has been strengthened through a new collaboration with the University of Guam.
Otago’s researchers helped establish SING Micronesia while in Guam in late 2024, as part of a project studying gout and other metabolic diseases in the Pacific.
The Summer internship for Indigenous Peoples in Genomics (SING) is an international consortium that develops opportunities for Indigenous peoples to engage in genomics research and education, including in New Zealand.
School of Biomedical Sciences Dean and project co-investigator Professor Lisa Matisoo-Smith FRSNZ says building capability in the Pacific is an on-going commitment for the co-designed gout research programme.
“It is a crucial part of ensuring Indigenous peoples can drive research with their own data,” she says.
“Establishing SING Micronesia was a good approach to progress this. Being part of the inaugural SING Micronesia workshop was a positive way to include indigenous CHamoru and other Micronesian voices and perspectives in genomic research in this corner of the Pacific.
“The workshops were an excellent opportunity to upskill students and researchers in bioethics and data sovereignty, as well as practical laboratory methods, applications and bioinformatic analysis.”
She says the success of SING Micronesia has also further cemented relationships between the two universities, and Otago is thrilled to have played a part in this.
Tristan Paulino, a PhD student at the University of Otago and lead organiser for SING Micronesia, says SING Micronesia has value now and into the future.
“SING Micronesia created a valuable platform for Indigenous Micronesians to address the historical distrust of research in the region, discuss strategies for engaging with current biomedical researchers, and set priorities for how genetic research and technology should be utilised within their own communities when the opportunity arises.”
Understanding how the genetic composition of Pacific people affects their metabolic health
A major Marsden Fund project that started in 2019 has been researching the genetics of metabolic disease in Pacific people.
The interdisciplinary and international team, led by Dr Anna Gosling and Professor Matisoo-Smith, with collaborators from the University of Guam and the University of Papua New Guinea (UPNG), set out to find the links between Pacific ancestry and the high rate of metabolic disease seen across the region.
Using the latest genomic and bioinformatics tools they have been looking for patterns to provide some answers on how ancestry, selection, and admixture (the mix of two different populations into a new population) have shaped Pacific genomes.

To date the team have collected samples and health data from over 800 people and have now sequenced whole genomes from more than half of those samples, from a range of Micronesian and Papua New Guinean communities, including Kiribati communities living in Aotearoa.
Lisa says better understanding of the evolution of metabolic disease will help to identify its prevalence and effects on Pacific peoples, their families and their communities.
Understanding its causes other than diet and lifestyle choices can also help to destigmatise metabolic diseases like gout, diabetes, and obesity.
“Ultimately, that information will help to target new treatments for diseases like gout, improving health and well-being for populations across the whole Pacific,” she says.
Three Pacific PhD students are working on the project. Tristan is completing his thesis on the Guam and Western Micronesian communities, and Bwenaua Biiri, originally from Kiribati, is researching metabolic disease in New Zealand Kiribati communities. Nigani Willie, from Papua New Guinea, is being funded by a Maurice Wilkins Centre PhD scholarship to study at Otago, looking at connections between gout and malaria in Papua New Guinea.
ORIGINALLY PUBLISHED: University of Otago
24-AUT-024 EIS Auckland University of Technology
24-BIA-001 EEB BioArch South
24-ESR-002 CMP Institute of Environmental Science and Research
24-FRI-006 EIS Scion
24-GNS-002 ESA GNS Science
24-GNS-003 ESA GNS Science
24-GNS-005 ESA GNS Science
24-GNS-007
24-HCA-001
24-LCR-001
ESA GNS Science
SOC Heather Came & Associates, NZ
Controlled liquid metal morphologies combining Chladni patterning and frequency regulated printed substrates
Dr Y Lv $360,000
Unearthing stories of early Māori ancestry and adaptation in Te Tai Tokerau Dr RL Kinaston $941,000
Understanding how lytic enzymes could allow drugs to breach membranes in bacteria causing illnesses such as salmonella, and pneumonia Dr C Billington
Looking for new pathways in sustainable energy by investigating reactions of glucose under electrocatalytic reduction
Investigating the threat from earthquakes in subduction zones that also rupture the overlying crust
Quantifying tsunami potential along Aotearoa’s Hikurangi subduction zone using a novel seismic imaging technique to better understand our most dangerous fault
The legendary Haowhenua earthquake: how big was it, and what would a repeat of it do to Wellington today?
What controls how deep magmas are before they erupt?
Imagining honourable kāwanatanga: preparing for a Tiriti-based future
EEB Manaaki Whenua Landcare Research Why are tuatara the only known reptile not prone to Salmonella?
24-LCR-016 EEB Manaaki Whenua Landcare Research Assessing insect species' declines and shifts in foraging breadth to understand changes in plant-pollinator networks
24-MAU-008 EEB Massey University
Determining whether three NZ alpine insects species freeze solid to survive the cold because they share the same gut microbes
24-MAU-016 EHB Massey University How caregivers influence the development of emotional dysregulation in young people and the subsequent impact on self-injury
24-MAU-028 SOC Massey University He kaupapa whakapakari kaimahi Māori hou: alleviating unique cultural pressures on Māori workers
24-MAU-037 SOC Massey University
Reduce, reuse, repair: new kinds of waste-conscious initiatives in circular and postcapitalist economies
24-MAU-054 ESA Massey University Elucidating why pyroclastic gas and ash flows cause so many volcanic fatalities
24-MAU-087
SOC Massey University
Exploring the hidden childcare struggles of parents working in a 24/7 economy
Dr B Song $360,000
Dr AR Howell $360,000
Dr BJ Tozer $360,000
Dr JC Rollins $360,000
Dr EC Hughes $360,000
Dr HA Came $757,000
Dr DMRL Middleton $941,000
Dr ML Donald $360,000
Professor M MorganRichards $941,000
Dr K Robinson $360,000
Professor JM Haar $870,000
Associate Professor KF Dombroski $870,000
Professor G Lube $941,000
Dr A Gallagher
$870,000
24-MEP-002 EHB Motu Economic & Public Policy Research Trust
24-NIW-057 ESA National Institute of Water and Atmospheric Research Ltd
24-PAF-020 CMP University of Canterbury
24-TWW-001 HUM Te Whare Wānanga o Awanuiārangi
24-TWW-002 HUM Te Whare Wānanga o Awanuiārangi
Building a database of inter-firm alliances in Aotearoa New Zealand, including alliances between Māori-led and nonMāori firms, and examining how firms navigate multiple outcomes in alliances
Quantifying the different types of strain along subduction zones to better understand Earth's greatest earthquake and tsunami hazards
How do plants hear the contrasting vibrations of a bee buzzing and a caterpillar chewing?
Ngā Kōrero Tawhito: using an archive of recordings of native te reo Māori speakers to assess the evolution of the language
Hau-ora Hau-mōteatea Hai whakaora i a-hau: examining the therapeutic and wellbeing potential of mōteatea
24-UNT-002 SOC Pūrangakura Ltd Māori, Pacific and Aboriginal women and the culturally re-generative community practices of making traditional clothing
24-UOA-005 MIS University of Auckland
24-UOA-023 SOC University of Auckland
University of California, Los Angeles
New ways of extracting and exploiting information from partial differential equations to solve pivotal problems in geometric analysis, representation theory, and fundamental physics
The evolution, impact and deployment of Pacific Research Methodologies and their relationship with Indigenous and Māori methodologies
24-UOA-027 EEB University of Auckland What is responsible for fern dispersal and diversity across the Pacific?
24-UOA-042 SOC University of Auckland What is a 'surplus' zoo animal and what should happen to them?
24-UOA-053 EEB University of Auckland Do mantis shrimps use one or two eyes to strike prey and predators accurately?
24-UOA-055 BMS University of Auckland
24-UOA-072 SOC University of Auckland
Understanding how central nervous system clearance could be targeted to intervene in aging brains and those with traumatic brain injuries
Centring Pacific girl gamers' voices in understanding how gaming contributes to their wellbeing, identity and relationships
24-UOA-081 SOC University of Auckland Me aro ki te hā o Hineahuone: the significant contribution of wāhine from Te Tai Tokerau
University of Auckland
University of Auckland
24-UOA-085 SOC University of Auckland Can we halt soil degradation through a new consideration of soil sovereignty?
Dr T Ryan-Charleton
$360,000
Dr GJ Crutchley
$940,000
Dr Samarth $360,000
Dr RT Collier
$360,000
Dr TR Tahi-Rangihau $360,000
Associate Professor HLJ Smith $360,000
Professor AR Gover $706,000
Dr MP Leenen-Young $870,000
Associate Professor FL Uperesa
Dr JMR Brock $360,000
Dr AP Palmer $360,000
Dr M Vorobyev $941,000
Dr JS Rustenhoven $941,000
Dr JMU Allen $360,000
Professor MJ Webber $859,000
Dr MSS Hetaraka
Dr CT Hoskins
Dr LJ Makey
$360,000
24-UOA-086 PCB University of Auckland
24-UOA-087 CMP University of Auckland
24-UOA-100 BMS University of Auckland
24-UOA-115 CMP University of Auckland
24-UOA-119 ESA University of Auckland
University of Canterbury
24-UOA-125 EIS University of Auckland
24-UOA-126 EHB University of Auckland
24-UOA-138 EIS University of Auckland
Unleashing the potential of titanium as a replacement for precious metal catalysts by affixing it to solid supports Dr RL Falconer $360,000
Understanding how temperature affects the circadian clock in legumes Dr MS Perez-Santangelo
Analysing whether a newly discovered complement evasion factor is useful in developing a vaccine against Group A Streptococcus
Understanding the origin of cell-cell interactions in the nervous system: how do bacterial teneurin homologues function?
TK Proft
Associate Professor JS Lott $941,000
Do local conditions around estuaries and lagoons amplify, preserve or diminish heating extremes from the ocean? Professor KR Bryan
Dr V Vetrova
Exploring whether nonlinear phaselocking can improve the generation of ultrashort pulses of laser light Dr YQ Xu $936,000
Understanding the historical drivers and possible futures of global cultural and linguistic diversity
Using a cutting-edge anatomical model of the heart and placenta to study the biomechanical elements of pregnancy that affect cardiovascular disease risk
24-UOA-153 MIS University of Auckland A logical framework for defining relational and graph databases to quantify processing difficulty and cost
24-UOA-163 EIS University of Auckland Unravelling the mechanisms that create environmental risks in "forever chemicals"
24-UOA-173 BMS University of Auckland
24-UOA-187 MIS University of Auckland
24-UOA-206 ESA University of Auckland
24-UOA-241 EEB University of Auckland
Free University of Berlin
24-UOA-245 HUM University of Auckland
24-UOA-248 EEB University of Auckland
Mapping how viruses get into and travel around B-cells in lymph nodes
Building theoretical foundations for algorithms employing linear algebraic techniques to take full advantage of cutting planes
Using Gallium to trace ancient microbial activity in geologic materials
Spying on the daily rhythm of a honeybee hive
How will a phonetician's work from 100 years ago alter our understanding of the evolution of modern New Zealand English?
Testing how the ability to distinguish kin from non-kin affects the evolution of genes, pathogens and species
Associate Professor SJ Greenhill $853,000
Associate Professor AR Clark $942,000
Professor SL Link $280,000
Dr S Yi $942,000
Dr ID Kelch $941,000
Dr M Vinyals $360,000
Associate Professor MC Rowe $941,000
Associate Professor GR Warman $941,000
Professor RHR Menzel
Professor CI Watson $660,000
Dr EA Ostrowski $941,000
24-UOA-260 EIS University of Auckland
24-UOA-268 BMS University of Auckland
24-UOA-279 MIS University of Auckland
24-UOC-019 EHB University of Canterbury
24-UOC-020 MIS University of Canterbury
24-UOC-046 CMP University of Canterbury
24-UOC-055 CMP University of Canterbury
24-UOC-058 EHB University of Canterbury
Analysing gastric bioelectrical patterns to develop non-invasive methods for identifying diagnostic biomarkers
Does mitochondrial function determine heat tolerance in diseased hearts?
Better ways to accurately model ice thickness and basal sliding in glaciers and ice sheets
Ngā Rōpū Kupu o Te Reo Māori: understanding the parts of speech in Te Reo Māori
Refining mathematical models of infectious diseases so we can better understand transmission in different population groups
Unravelling the mechanisms that enhance the spread of pathogenic "biological bulldozers"
Shedding insight on how plants coordinate their reaction to stress on a molecular level
The differences between 'super-matchers' and forensic science experts when sampling visual information
24-UOC-097 ESA University of Canterbury Tracking cosmic-ray particles to their source using multimessenger and multiwavelength observations
24-UOC-125 PCB University of Canterbury
Building on the discovery of a new category of glass to create structurally resilient glasses formed from hybrid perovskites that have promising application in photovoltaics and LEDs
24-UOC-137 EIS University of Canterbury Can we control fluids sprayed by rotary atomizers by alterating the shape of the rotating surface?
24-UOC-144 HUM University of Canterbury Examining which syllables are stressed in te reo Māori and why
24-UOO-012 CMP University of Otago How does Streptococcus pneumoniae, the main cause of community acquired pneumonia and meningitis in children and the elderly, acquire a critical antioxidant from its host to survive at infection sites?
24-UOO-017 EIS University of Otago Understanding how cells generate largescale tissues
24-UOO-023 MFC University of Otago Fostering children's brain development, self-regulation, and academic skills with Kia Tīmata Pai (Best Start study)
University of Auckland
University of Waikato
24-UOO-027 EHB University of Otago Unravelling how the brain recreates multisensory phenomena to better understand maladaptive eating behaviour
Dr R Avci $360,000
Dr ASC Power $360,000
Dr RV Nicholson $360,000
Dr FA Panther $852,000
Professor MJ Plank $706,000
Associate Professor A Garrill $940,000
Dr CN Meisrimler $940,000
Dr B Growns $360,000
Professor JA Adams $941,000
Professor TD Bennett $941,000
Professor M Sellier $942,000
Dr K Culhane $360,000
Dr N Dickerhof $941,000
Dr FM Yavitt
$360,000
Professor JE Reese $3,000,000
Professor JM O’Sullivan
Professor VM Reid
Dr M Peng
$853,000
24-UOO-041 BMS University of Otago
Understanding the role of efflux pumps in the evolution of untreatable multidrug resistant strains of Mycobacterium tuberculosis
24-UOO-045 HUM University of Otago Kia Hauora Anō: the first historical study on the nature and impact of war wounds and disease on Māori veterans of WWII
University of Otago
24-UOO-053 BMS University of Otago
24-UOO-056 EHB University of Otago
Takarangi Research Ltd
24-UOO-063 BMS University of Otago
24-UOO-065 PCB University of Otago
University of Otago
24-UOO-069 BMS University of Otago
24-UOO-071 MIS University of Otago
24-UOO-103 CMP University of Otago
24-UOO-107 CMP University of Otago
24-UOO-111 EEB University of Otago
24-UOO-118 BMS University of Otago
24-UOO-153 PCB University of Otago
University of Otago
24-UOO-160 BMS University of Otago
University of New South Wales
24-UOO-168 BMS University of Otago
24-UOO-179 CMP University of Otago
Revealing how the brain becomes desensitised to stressful experiences
The bioethics of use, curation, and repatriation of anatomical skeletons in Aotearoa
Identifying the mechanism that coordinates menopausal hot flushes and sleep disturbance
Modifying the transmission of light through quantum-controlled light scattering
How maternal hormones affect the olfactory system and parental behaviour
Statistical methods for mitigating uncertainty in complex networks of infrastructure assets
Understanding how the brain governs sex change in fish: why can the NZ spotty wrasse change sex while other species can't?
The molecular mechanisms driving gastric cancer survival rates: understanding the role of nuclear immunoproteasomes
Using recent genomic advances to investigate why biocontrol of parastitic wasps is declining over time
Preserving and repairing heart function with suPAR after a heart attack
Exceptional control of quantum states: non-Hermitan physics and magnonpolaristons near exceptional points
Unravelling the link between depression and heart disease by examining serotonin and Lp(a) catabolism
Investigating how cohesin organises DNA in neurons and the impact of cohesin deficiency on brain function
The mechanical and biological significance of a reversible switch that controls protein function in cell division regulation
Dr MB McNeil $941,000
Professor AC Wanhalla $660,000
Dr CL Macindoe
Dr JS Kim $940,000
Professor SE Halcrow $853,000
Dr JA Metzger
Dr J Clarkson $941,000
Professor N Kjærgaard $941,000
Dr MA Chilcott
Dr RSE Brown $941,000
Dr X Xiao $360,000
Dr K Kamstra $360,000
Dr S Neumann $360,000
Dr SN Inwood
$360,000
Dr JSC Chew-Harris $360,000
Associate Professor HGL Schwefel $941,000
Dr NJ Lambert
Professor SPA McCormick $941,000
Dr GMI Redpath
Professor JA Horsfield $941,000
Dr C Goebl $941,000
24-UOO-180 EIS University of Otago Improving the technology used to measure abnormal stiffness in cells by using sculpted light at a microscopic scale
24-UOO-184 PCB University of Otago A new, milder way to guide toxic drugs to cancer cells
University of Otago
24-UOO-196 EIS University of Otago
24-UOW-002 EEB University of Waikato
24-UOW-005 SOC University of Waikato
24-UOW-007 SOC University of Waikato
University of Waikato
Using frequency-comb spectroscopy to transform an optical spectrum into the digital domain in near real-time
Investigating how light affects green nectaries so we better understand the vital flower parts that generate nectar and attract animal pollinators
Creating a demographic database of iwi, hapū and kāinga in the 19th century to better understand population change during colonisation
Building understanding about intersex children's bodily integrity and human rights
24-UOW-011 EHB University of Waikato Combining te ao Māori concepts with contemporary economic methods to build a model of the Aotearoa New Zealand economy that analyses and quantifies intergenerational wellbeing
EMPlan Services Ltd
24-UOW-013 SOC University of Waikato Tiaki tāne: kaupapa Māori approaches to exploring causes of youth offending for rangatahi tāne Māori
Mana Pounamu Consulting, NZ
24-UOW-032 EEB University of Waikato Unravelling the winter survival strategies of Antarctic cyanobacteria in the geothermally heated soils of Mt Erebus
24-UOW-033 EEB University of Waikato Tracking how viruses are distributed globally through the atmosphere to better understand whether melting Antarctic ice will release old viruses
24-UOW-049 HUM University of Waikato
Engaging 21st century uri (descendants) with 19th century tūpuna critiques of colonial violence
24-UOW-064 ESA University of Waikato Using isotopes to determine whether life originated and evolved on a hot or cold Earth
24-UOW-066 SOC University of Waikato Ngā Hua o Tōna Ahurea Māori: measuring the adaptive outcomes of Māori cultural embeddedness
24-VUW-003 EHB Victoria University of Wellington Mā te tāke tika, e mau roa te iwi: with a just tax system, the people are sustained. Researching a Te Tiriti-affirming tax system design
Victoria University of Wellington
Dr MA Taylor $942,000
Associate Professor AB Gamble
Dr JM Fairhall
$941,000
Dr F Sedlmeir $360,000
Associate Professor MJ Clearwater $941,000
Professor TH Kukutai
$870,000
Professor K Roen $868,000
Professor CM Breen
Professor LT Oxley $849,000
Dr GM Penny
Dr LA Tompson $869,000
Dr PJWE Aikman
Dr SE Noell $360,000
Professor IR McDonald $941,000
Dr SJ Iti Prendergast $360,000
Dr TT Isson
Dr RF Fox
$941,000
$360,000
Professor LJ Marriott $853,000
Dr BJ Tunui
24-VUW-006
24-VUW-010
24-VUW-014
HUM Victoria University of Wellington
HUM Victoria University of Wellington
MIS Victoria University of Wellington
24-VUW-021
PCB Victoria University of Wellington
24-VUW-028 EHB Victoria University of Wellington
What drives the rise of indigenous nonreligion and how does it connect to broader trends? A comparison between Aotearoa New Zealand and Canada
Death’s impact on privacy, reputation and mana. A comparative exploration of Pākehā law and tikanga Māori
Collaborating to use a twisted groupoid approach to solve problems in abstract and operator algebra, thus advancing a mathematical framework for quantum mechanics
Developing an efficient photonic analogue of an electronic memory resistor that will allow ultra-fast, energy-efficient optical computing
Using an AI simulation of a young child to test whether a positive framing of autism can help families better support their autistic children
24-VUW-050 MIS Victoria University of Wellington Contributing to the debate on the definition of C*-algebras of semigroups, the mathematical foundation of quantum mechanics
24-VUW-060
SOC Victoria University of Wellington
24-VUW-072 BMS Victoria University of Wellington
24-VUW-081
EIS
24-VUW-096
Victoria University of Wellington
Massey University
What are the implications of policing climate justice activism?
Protecting infants from infectious disease by amplifying antibodies in breast milk
Producing next-generation materials that can capture methane
PCB Victoria University of Wellington Do bacteria from New Zealand insects hold solutions for new anti-microbial drugs?
24-VUW-100 HUM Victoria University of Wellington How 18th century poetry influenced settlers' treaty making with indigenous peoples
24-VUW-103
24-VUW-106
SOC Victoria University of Wellington
BMS Victoria University of Wellington
24-VUW-124 MIS Victoria University of Wellington
Victoria University of Wellington
Exploring how New Zealanders with ADHD experience and manage their Internet use
Pioneering precision tools for enzymebased targeted cell ablation to improve our understanding of regenerative and developmental cell biology
Methods for identifying clusters and making predictions of cluster membership in survey data analysis
Dr S Rahmani $360,000
Professor NA Moreham
Dr B Armstrong $360,000
Dr JJ Schuyt $360,000
Dr HL Waddington $360,000
Professor A An Huef
$706,000
Dr AC Thomas $360,000
Dr IFN Montgomerie
Dr L Liu
Professor SG Telfer
Dr RF Little
Professor NA Hessell
Dr AMD Beattie
Dr AV Sharrock
$360,000
$942,000
$360,000
$660,000
$360,000
$360,000
Associate Professor I Liu $706,000
Professor RA Arnold
24-VUW-125
EHB Victoria University of Wellington
The relationship between positive autobiographical memory and emotional well-being in older adults
Dr MT Crawford
$853,000
24-VUW-134 PCB Victoria University of Wellington
Developing a new, flexible, low-cost class of organic solar cells that convert sunlight directly into electricity
Dr PA Hume $941,000
24-VUW-145 MIS Victoria University of Wellington How continous antenna arrays affect communication over Gaussian fields Professor PJ Smith $706,000
24-VUW-148 MIS Victoria University of Wellington
Developing models of reputation dynamics, to explore how scrutiny and social standing generate cooperation among strangers
24-VUW-152 BMS Victoria University of Wellington Stabilising Mucosal-associated invariant T (MAIT) cells for use in pill-based colorectal cancer therapy
Yamaguchi University
The list is abridged.
For the complete list of awarded Marsden Fund investigators, including abstracts of all projects, visit Bit.ly/MF60-128
Frean
Associate Professor BL Stocker
Dr K Shibata
$941,000

Whakapā mai | Contact us
Marsden Fund Te Pūtea Rangahau a Marsden
Royal Society Te Apārangi
11 Turnbull Street
Wellington 6011
PO Box 598
Wellington 6140
New Zealand
+64 4 470 5799 marsden@royalsociety.org.nz royalsociety.org.nz
Ngā tūhonohono | Connect with us
ISSN 1175-0073
Published 2025